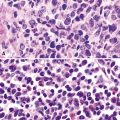

20 Malignant and Borderline Mesothelial Tumors of the Pleura
The number of publications on the pathologic features of primary pleural mesothelial tumors has gone from meager to innumerable in a little over 40 years. As late as the 1960s, a strong opinion in the medical community held that a diagnosis of malignant mesothelioma (MM) could not be established with certainty during life and that neoplasms effacing the serosal lining of the chest cavity were probably metastatic from other sites.1 Accordingly, a diagnosis of MM was largely consigned to autopsy pathologists.
Another problem, which persists to some extent even today, relates to the widely cited paradigm for classification of mesothelial tumors that was first advanced by Klemperer and Rabin in 1931.2 Those authors divided these lesions into four broad categories, depending on whether they were benign or malignant and localized or diffuse. However, using that model, such neoplasms as solitary fibrous tumors and pleural sarcomas, which are not mesothelial at all, are still confused by some clinicians with true MMs.
Malignant Mesothelioma
Clinical Findings in Pleural Mesothelioma
Patients with malignant pleural mesothelioma are typically adults older than 50 years of age,3–6 but there have also been several well- documented examples of this tumor in children.7–9 Very rarely, familial clustering of MM has been reported, with parent-child or sibling-sibling combinations being represented.10–13 To date, there have been no reports of spouse-spouse concurrences.
The most common presentation of MM is with progressive shortness of breath.4,5,14,15 Unilateral chest pain is also relatively frequent, and this may or may not have pleuritic characteristics. Another rarer manifestation is that of flulike illness, with malaise, anorexia, low-grade fever, myalgias, and weight loss.16–19 Distant metastasis of MM to extrathoracic lymph nodes or other anatomic sites at presentation is extraordinarily uncommon20,21 but can represent a diagnostic challenge for pathologists.
Plain film chest radiographs typically show a unilateral pleural effusion, which may be massive in volume despite relatively minor symptoms (Fig. 20-1). Reimaging after thoracentesis often reveals diffuse pleural thickening; more rarely, a single discrete pleural mass may be observed.22–25 Computed tomography and magnetic resonance imaging scans of the thorax are more sensitive than plain films for demonstrating tumor volume and invasion of contiguous anatomic structures25–27 (Fig. 20-2). They are also superior for showing the presence of pleural plaques and pleural calcifications, which are sensitive markers of asbestos exposure. One or both of these markers are seen in 85% or more of all individuals who are exposed to asbestos at an above-background level.28,29
Other laboratory abnormalities in MM cases are relatively few and nondescript. However, a substantial proportion of patients have tumor-related thrombocytosis, with platelet counts greater than 400,000 mm3.30–33This may relate to the elaboration of interleukin-6 by the tumor cells, inasmuch as that cytokine is known to stimulate thrombopoiesis and is often elevated in both pleural fluid and serum in individuals with MM.34 As expected, an excess of thrombotic events is associated with MM-related thrombocythemia.30
It must be emphasized that none of the clinical findings just mentioned is specific for MM and may also be encountered in connection with other primary pleural neoplasms or metastases to the pleura. In particular, the peculiar form of lung cancer known as pseudomesotheliomatous (pleurotropic) adenocarcinoma (see Chapter 16) is capable of reproducing the symptomatic and radiographic constellation of abnormalities associated with mesothelioma34–38 (Fig. 20-3).
Video-assisted thoracoscopic surgery (VATS) is now the preferred method for obtaining diagnostic pleural tissue.39–41 VATS (Fig. 20-4) is superior to cytologic sampling of pleural fluid and closed-needle biopsies because of its much greater yield. VATS also produces a specimen of sufficient size for visualization of microarchitectural landmarks. In addition, the morbidity associated with this method is very low. Finally, cytologic examination of pleural fluid in VATS produces positive results in only a minority of cases. This may be because the free surfaces of MMs may be coated with a layer of fibrinoinflammatory exudate, possibly with a misleading benign mesothelial reaction. This process may “wall off” the tumor cells and prevent them from shedding freely into the pleural fluid.42,43
One unwanted but well-reported complication of thoracic biopsies in MM is the growth of tumor along needle or instrumentation tracks in the chest wall.44,45 The reason for this peculiar behavior is currently unknown.
In general, once the clinical presence of diffuse pleural MM has been established, ensuing survival is limited. Most patients live roughly 1 year after diagnosis, regardless of the therapeutic intervention used.46–49 However, a small minority of individuals with good overall performance status and limited intrathoracic disease may be candidates for extrapleural pneumonectomy.49,50 This procedure has resulted in lengthened median survival in some published series50; however, a significant proportion of patients go on to demonstrate the presence of distant metastases of MM under such circumstances, perhaps because of this shift in the natural history of the tumor. Radiotherapy has also been given after extrapleural pneumonectomy, especially for the attempted salvage of patients with recurrent tumor.49 Nevertheless, along with most chemotherapeutic approaches and immunomodulation,51 this treatment modality has not produced uniformly encouraging results. An epithelial histologic subtype, a favorable overall performance score, relatively young age, and the absence of chest pain are all correlated with better survival.18
A more favorable prognosis is also associated with localized malignant pleural mesothelioma, a rare lesion.52–54 It often grows preferentially into the soft tissue of the chest wall rather than along the pleural surface and, thus, presents itself as a discrete mass. Radical surgical removal of localized mesothelioma results in long-term survival in up to 50% of cases.54
Etiologic Considerations in Pleural Mesothelioma
However, the nearly ubiquitous involvement of attorneys in mesothelioma cases, as part of the burgeoning field known as “toxic tort” law,55 has compelled physicians to acquire a working familiarity with the pathogenetic underpinnings of MM. Because of this reality, a brief review of that subject will be provided here; additional information is presented in Chapter 9, which deals specifically with pneumoconioses.
In the early- to mid-1960s, a causal connection between high-level inhalation of amphibole-class asbestos fibers and mesothelioma was first established to the satisfaction of the medical community at large, through the efforts of Wagner and colleagues and others.56–59 At first, epidemiologic surveys were the principal tools whereby this association was identified. However, this avenue of investigation, in which exposures are ascertained primarily by word-of-mouth information, is applicable to patient groups rather than individuals. In the current social environment of the 21st century, epidemiologic questioning and medical history taking are plagued by significant problems in trying to determine the causation of any given case of MM. This is true because media-related exposure of the potential linkage between mesothelioma and asbestos has been robust. Therefore, patients with MM are inculcated with the belief that they must have been exposed to asbestos somewhere and somehow in the past. Moreover, another very real issue concerning the pathogenesis of MM is whether chrysotile-type asbestos—the most commonly used representative of the mineral group in the past several decades—is effective as a carcinogen in this specific context. Aggregated data suggest that chrysotile has very weak mesothelioma genesis.60–63 Hence, asbestos exposure as a generic term has an indefinite and imprecise meaning for individual patients in the absence of other data.64
Fortunately, objective information is available to address this area of causation. This is important not only for the legal system—where it can be used to provide concrete fact instead of hearsay—but also for physicians who are committed to the principles of evidence-based medicine. Examination of pathologic specimens continues to be a linchpin in this setting. If conventional light microscopic scrutiny of sections of lung parenchyma demonstrates asbestos bodies at an above-background density (Fig. 20-5), or these structures are seen in intrathoracic lymph nodes, it may be concluded that a mesothelioma in the same case is indeed asbestos-related. Similarly, the radiographic or pathologic presence of pleural plaques, pleural calcifications, or rounded atelectasis (Fig. 20-6) serves a comparable purpose.65–67 Ultimately, the most direct and best approach to evaluating the presence of asbestos in lung tissue is to perform a digestion analysis of representative parenchymal samples (Fig. 20-7), comparing the density of asbestos fibers found by such methods to that which is present in a carefully assembled age-matched and sex-matched control population, acquired from the same geographic region as that in which the patient lived.68
Using the last of these techniques, Roggli and associates have shown that a bimodal distribution of pulmonary asbestos burdens is associated with pleural MMs.69 The majority of patients (group I) have a density of asbestos bodies above 20 per gram of wet lung tissue. The remaining patients (group II) manifest an asbestos burden identical to that seen in appropriate reference cohorts. These data strongly support the conclusion that group II MMs are not etiologically related to asbestos, and, in the absence of other potential causes (see later discussion), these cases are properly termed “idiopathic” or “spontaneous” mesotheliomas. Practically speaking, one can use the latter designation if no objective support for asbestos causation is apparent in a case in question, based on a review of thoracic imaging studies, pleuropulmonary tissue biopsies, or autopsy specimens of lung and pleura.70
The proportion of MMs that is idiopathic in nature has varied from study to study in the published literature, probably as a function of geographic and chronologic bias.71 Cited percentages have generally been between 25% and 40% of all pleural mesotheliomas.72 In our experience in recent years, using the objective approach just outlined, approximately 40% of MMs are spontaneous neoplasms with no definable etiologic linkage to asbestos.
Pleural mesotheliomas that are caused by asbestos develop after a long latency period, typically longer than 20 years in duration.73 The reason for this hiatus is not clear, but it appears that the carcinogenic effect of this mineral group requires a prolonged time—and probably a complicated set of intermediate cellular events74–76—to become manifest. Attanoos and coworkers77 have described a remarkable group of nine asbestos-related mesothelioma cases (eight of which concerned pleural tumors) in which a second concurrent malignancy was present as well. Six of the patients had bronchogenic carcinomas—accompanied by pulmonary asbestosis in five—and the remaining individuals had colorectal, breast, and pancreatic carcinomas. The nine patients in that series represented 1.8% of all mesothelioma cases seen at our institutions.
Other documented etiologies for pleural MM besides asbestos undeniably exist.70,71,78,79 These include prior therapeutic irradiation to the anatomic region in which the mesothelioma develops80–85; chronic serosal inflammation, such as that associated with tuberculosis, pleural empyema, familial Mediterranean fever, or chronic collagen vascular diseases (e.g., rheumatoid arthritis or lupus erythematosus)86–89; membership in familial cancer kindreds (“Lynch families”)12,13,90; prior administration of thorium dioxide (Thorotrast), a radiologic imaging agent91,92; and inhalational exposure to erionite, another mineral group.93,94 Infection with Simian virus-40 has recently been examined as another possible cause of human mesothelioma, with contradictory, but usually negative, conclusions.95–100
Interestingly, mesothelioma is a well-documented malignancy of cattle and other animals (both wild and domesticated), and the clinicopathologic attributes of such animal tumors are comparable in every way to those of spontaneous human MMs.101–107 Further attention to the potential pathogeneses of veterinary mesotheliomas could possibly be illuminating in a mechanistic sense.
Gross Features of Pleural Mesothelioma
However, more typically, clinical abnormalities are accompanied by multifocal “studding” of the visceral or parietal pleural surfaces, or both, by firm white-gray nodules that individually measure up to several centimeters in diameter. With time, these become innumerable and confluent, obliterating the pleural cavity and often forming a thick layer of constricting neoplastic tissue (Figs. 20-8 and 20-9). Invasion of contiguous structures, including the peripheral lung parenchyma, pericardium and myocardium, adventitia of the great thoracic blood vessels, and soft tissue of the chest wall, is common as tumor growth advances. In addition, mesotheliomas of the pleura may cross the central apertures of the diaphragm to secondarily involve the peritoneal cavity,108 and they are also capable of crossing the mediastinum to involve the contralateral hemithorax. If the patient survives long enough, the terminal image of the tumor may be that of a dense rind of tissue that encases the viscera of the chest.109 Grossly visible metastases in regional lymph nodes and distant sites may also be appreciated, but they generally appear only late in the clinical course. It should be noted that there is nothing specific about the macroscopic characteristics just outlined. They are potentially common to MM, metastatic carcinoma in the pleural spaces, pleural lymphoma, and primary pleural sarcomas.34–36,110,111
Solitary (localized) MMs of the pleura most often grow exophytically into the soft tissue of the chest (Fig. 20-10) or, alternatively, into the subjacent lung parenchyma, rather than spreading along the serosal surfaces.54,112 As such, they can macroscopically simulate peripheral carcinomas of the lung.
Cytopathologic Features of Pleural Mesothelioma
Mesothelial proliferations in the pleura have a wide spectrum of potential cytomorphologic appearances and can rightfully be included in several generic cytologic categories that encompass small round cell tumors, polygonal cell malignancies, spindle cell and pleomorphic lesions, and neoplasms with mixed cellular features.113 However, traditionally, three broad histopathologic patterns of mesothelioma have been considered: epithelial (including tubulopapillary, oncocytoid/deciduoid, clear cell, and small cell subtypes), sarcomatoid (including desmoplastic and “lymphohistiocytoid” variants), and biphasic. These lesions may, on occasion, show other unusual histopathologic features, such as the presence of extensive myxoid change, “glomeruloid” features, adenomatoid tumor-like images, “rhabdoid” features, and metaplastic formation of bone and cartilage.
Epithelial mesothelioma is composed of sheets and clusters of variably atypical epithelioid cells in effusion cytology specimens. Such samples are typically densely cellular (Fig 20-11). Mitotic figures and background necrosis are uncommon, but these two features may certainly be apparent in high-grade lesions. Epithelial MMs may also show papillary or tubular cell groups (Fig. 20-12), and, in thoracentesis specimens, the malignant cells may be surprisingly bland cytologically.114–119 Conversely, benign reactive mesothelia can show an alarming degree of nuclear atypia, compounding the difficulty of their diagnostic separation from malignancies.116,120 Groups of both reactive and neoplastic mesothelial cells may demonstrate intercellular spaces or “windows,” and sufficient dispersion of such elements shows the presence of fuzzy cell membranes due to the presence of elongated plasmalemmal microvilli (Fig. 20-13). Nuclear-to-cytoplasmic ratios are high in obviously anaplastic MMs, but this finding may not be characteristic of all tumors. Small cell epithelial mesothelioma demonstrates tightly clustered cell groups with scant cytoplasm and no obvious microvilli. It may be exceedingly similar cytomorphologically to other small cell malignant neoplasms, particularly small cell neuroendocrine carcinoma121 (Fig. 20-14).
Figure 20-12 A tubular profile of tumor cells is apparent in this pleural fluid cytology preparation of malignant mesothelioma.
Sarcomatoid mesothelioma contains cytologically malignant dyshesive fusiform cell proliferations that cytologically imitate other tumors of mesenchymal origin (i.e., sarcomas)122 (Fig. 20-15). In pleural effusions, the tumor cells of sarcomatoid MM are few in number if they are present at all, with scant cytoplasm, elongated nuclei, and rare mitotic figures. A subtype of this variant is the desmoplastic mesothelioma, which is characterized histologically by a bland appearance of the spindle cells that are embedded in a hypocellular, abundantly collagenized stroma.123 As one might expect, diagnostic tumor cells from desmoplastic tumors rarely, if ever, are shed into effusions.
In the past, “lymphohistiocytoid” mesothelioma was regarded as a sarcomatoid MM variant,124 but it actually bears more resemblance to lymphoepithelioma-like carcinomas of various organs than to true sarcomas.125 In this lesion, one sees syncytia of polyhedral cells with prominent nucleoli, admixed with numerous mature lymphocytes. Biphasic mesotheliomas manifest a combination of the cytomorphologic patterns that are expected in epithelial and sarcomatoid tumors.115
Many pathologists are still reluctant to make a diagnosis of mesothelioma based only on effusion cytology specimens, in light of the pitfalls mentioned above. However, our experience over time has shown that this hesitancy is often unnecessary. If several pleural fluid samples in a given case consistently show dense cellularity, an overwhelming dominance of cells with clearly mesothelial morphologic features, three-dimensional cellular aggregates, and at least some nuclear atypia, a diagnosis of MM is likely. This interpretation can be solidified by preparation of cell block sections (Fig. 20-16) and the application of adjunctive studies.126,127 Therefore, a conclusive opinion can indeed be rendered by the cytopathologist in a sizable proportion of mesothelioma cases.
Kimura and colleagues128 have proposed that a scoring system be applied as an aid in this process. Using a scale with a maximum value of 10, these authors assigned one point to each of the following features, in favor of an ultimate diagnosis of MM: variety of cell size, cytoplasmic cyanophilia with visible microvilli, sheetlike cell arrangement, “mirror ball”–like cell groups, obvious nuclear atypia, and cell cannibalism. Two-point values were assigned to the presence of large acidophilic nucleoli and to multinucleated cells with more than eight nuclei. In an analysis of 22 MMs, with 20 cases of conditions featuring benign mesothelial atypia and 50 examples of metastatic carcinoma, the “Kimura system” was effective at separating mesotheliomas, which had scores of more than five, from the other specified lesions.128
Histopathologic Features of Pleural Mesothelioma
Mesothelioma generally, but not always, spreads multifocally throughout the pleural soft tissues, demonstrating invasion of the peripheral-most subpleural lung tissue in many cases. Other uncommon histologic patterns of growth include129 lymphangitic spread in the lung (Fig. 20-17); pulmonary alveolar permeation through the pores of Kohn, mimicking organizing pneumonia (Fig. 20-18); and lepidic intrapulmonary growth, mantling alveolar septa.
Figure 20-17 Lymphangitic intrapulmonary growth of pleural mesothelioma is seen in this photomicrograph.
There is no substantial difference between the histology of untreated and residual treated mesotheliomas.130
Epithelioid Mesothelioma
Epithelioid malignant mesothelioma (EMM) is the most commonly encountered microscopic subtype.131 In the majority of cases, the lesion is composed of sheets and nests of polyhedral cells with moderately atypical nuclear features, clear infiltration of the pleural soft tissue or subjacent lung, or both. Lesions comprising uniform expanses of densely apposed polygonal cells are known as “solid” epithelioid MMs (Fig. 20-19). In other tumors, glandlike profiles are common; indeed, some cases demonstrate a predominance of such structures, prompting use of the terms “tubular” or “pseudoglandular” EMM. Micropapillary cell groups are also frequent, and, when they uniformly characterize the lesion, the term “tubulopapillary” MM is rightly applied (Fig. 20-20). This subtype of mesothelioma may be particularly associated with lymphatic invasion and lymph node metastasis.132 Although psammomatous microcalcifications are associated with other epithelial malignancies having a papillary configuration, they are only rarely seen in pleural mesotheliomas.133
Figure 20-19 A and B, “Solid” malignant mesothelioma of the pleura comprising confluent sheets and nests of polygonal tumor cells.
Figure 20-20 A and B, Tubulopapillary malignant pleural mesothelioma demonstrating micropapillary profiles of polyhedral cells.
A useful diagnostic finding in EMM concerns the tinctorial properties of the tumoral stroma. Lightly hematoxylinophilic and myxoid material may be seen between epithelioid cell groups in this lesion, representing the presence of stromal mucin.134 Although it is not specific, this observation does favor an interpretation of MM over one of carcinoma. An extension of the same property is reflected by the cytoplasmic characteristics of some tumor cells in EMM, which demonstrate macrovacuoles having a bluish cast (Fig. 20-21). These probably represent intracellular inclusions of the same stromal material.
“Lymphohistiocytoid” mesothelioma has been mentioned earlier. To recapitulate, it has a histologic appearance that is markedly similar to that of lymphoepithelioma-like carcinoma (Fig. 20-22).
One subtype of EMM has been called “deciduoid” mesothelioma because of the impression that its constituent cells resemble those of decidua in the female genital tract.135–137 As such, they assume a large polygonal cell image with relatively abundant eosinophilic cytoplasm and oval vesicular nuclei. This relatively bland appearance belies the invasive nature of deciduoid MM, the biologic features of which are comparable to those of other forms of mesothelioma. Synonyms for this variant are “oxyphilic” or “oncocytoid” MM.101
Another form of EMM contains polyhedral cells with strikingly lucent cytoplasm and is accordingly known as “clear cell” mesothelioma138–140 (Fig. 20-23). This variant is extremely uncommon, at least in pure form, and is also related to “foam cell” or “lipid-rich” MM.125
Rarely, foci in EMM may simulate the microscopic appearance of pleural adenomatoid tumors (see Chapter 19), with bland microcystic glandlike profiles composed of compact epithelioid cells.141 However, other areas in those lesions typically have the conventional image of ordinary mesothelioma.
“Glomeruloid” mesothelioma is a relatively recently described variant in which the tumor cells form peculiar arrays that resemble glomeruli in the renal cortex (Fig. 20-24).142 Again, its behavioral properties are no different than those of ordinary EMMs.
Mention must also be made here of the concept of mesothelioma in situ. This term has been applied to cytologically atypical proliferations of epithelioid mesothelial cells that are confined to the pleural surface, with no evidence of invasion across its basement membrane143,144 (Fig. 20-25). Reports on this finding have been limited to cases where other areas of the pleura did demonstrate infiltrative MM. Hence, it is still not clear as to whether pleural mesothelioma can truly exist in an exclusively in situ form. In fact, we have never seen an autopsy case that involved this finding.
Sarcomatoid (Spindle Cell) Mesothelioma
Sarcomatoid malignant mesothelioma (SMM) (also see Chapter 14) is comprised of fusiform cells with variable degrees of atypia and pleomorphism.122,131,145–147 These may be arranged in fascicles, storiform arrays, or random configurations (Figs. 20-26 and 20-27). Tumoral collagen synthesis is likewise heterogeneous. The prevalence of mitotic activity and necrosis in such lesions generally parallels their histologic grade. A special variant of SMM is that which shows divergent differentiation into “heterologous” mesenchymal tissues such as osteoid, cartilage, and striated muscle (Fig. 20-28).148–150 It could rightly be called “metaplastic” SMM. Tumors with angiosarcoma-like foci in this category have also been termed “pseudovascular” or “angiomatoid” mesotheliomas (Fig. 20-29). Klebe and associates have suggested that all pleural neoplasms with purely sarcomatous features should be classified as mesotheliomas, even if they are immunohistologically negative for keratin.151 We cannot agree with that conclusion, because, as discussed subsequently, their experience is that SMMs express keratin in virtually every case regardless of morphologic nuances.
Figure 20-28 A and B, Divergent osteochondroid differentiation in sarcomatoid malignant pleural mesothelioma.
Figure 20-29 A histologic resemblance to angiosarcoma is seen in this “pseudovascular” mesothelioma.
Myxoid stroma may also dominate the microscopic picture in occasional examples of SMMs. When cellular atypia in sarcomatoid mesothelioma is extreme, the designations “anaplastic” or “pleomorphic” MM are appropriate.152
Desmoplastic Mesothelioma
As mentioned earlier, desmoplastic malignant mesothelioma (DMM) is a special subtype of SMM in which spindle-shaped or stellate neoplastic cells are bland cytologically and have a low density per unit area.123,153–155 They are set in a markedly collagenized and hyalinized stromal matrix, often with a “basket weave” configuration like that of pleural plaques or fibrohyaline pleuritis (fibrous pleurisy)123 (Fig. 20-30). Mitoses are sparse, and necrosis is limited if it is present at all. The World Health Organization recommends that the designation DMM be used when more than 50% of the tumor shows this pattern. Many SMMs and some biphasic tumors (see later discussion) also contain small foci in which a desmoplastic foci can be seen; in such cases mention of such foci is recommended, because this variant has a particularly poor prognosis.
The malignant nature of DMM is manifested by its invasion of underlying lung or adjacent soft tissues156 (Fig. 20-31). In addition, careful scrutiny of the tumor usually (but not always) reveals a level of cellular atypism and a degree of cellular density that exceeds that of benign pleural lesions (Fig. 20-32). Moreover, there is no microscopic “zonation” in DMM. That phenomenon is best represented in fibrohyaline pleuritis, in which lesional cellularity decreases as one moves spatially from the pleural space into the subjacent tissues.157 The Verhoeff-Van Gieson elastic stain is helpful in the differential diagnosis of fibrohyaline pleuritis versus DMM. Mesotheliomas show a paucity of internal elastic fibers, or, if they are present, there is no regularity of their orientation. In contrast, fibrous pleuritis usually exhibits a retention of laminated, roughly parallel elastic tissue throughout the thickened visceral pleura (see Chapter 18).
Biphasic Mesothelioma
As their name suggests, biphasic malignant mesotheliomas are typified by admixtures of two morphologic configurations, usually at least one variant of EMM and at least one in the spectrum of SMM. Those components may be abruptly juxtaposed to one another or blend imperceptibly131 (Fig. 20-33). Schramm and coworkers have suggested that biphasic malignant mesotheliomas typify the “epithelial-mesenchymal” transition that can be seen in several tumor types, and that this phenomenon worsens the behavior of epithelial neoplasms.158
Small Cell Mesothelioma
Another uncommon type of MM is its small cell form, a variant of epithelial MM.121,159 It is only rarely seen in “pure” form and usually includes a portion of tumors with other histologic patterns. This lesion is composed of compact round cells with high nuclear-to-cytoplasmic ratios, oval nuclei with dispersed chromatin, variably discernible nucleoli, and scant amphophilic cytoplasm (Fig. 20-34). As such, it is morphologically similar to several other malignant small cell/basaloid neoplasms, including basaloid carcinoma, high-grade neuroendocrine carcinoma, small cell melanoma, small round cell sarcomas, and non-Hodgkin lymphomas.
Rhabdoid Mesothelioma
Over the past decade, it has become apparent that a relatively broad spectrum of malignant tumors may exhibit a “rhabdoid” phenotype, akin to that seen in high-grade pediatric renal neoplasms. Extrarenal rhabdoid tumors (ERTs) may be “pure” histologically, or they may represent a new clonal element that has arisen from another recognizable tumor type.160 Hence, one may see ERTs in combination with a definable carcinoma, melanoma, or sarcoma. In the latter instance, the term “composite” ERT is apropos. MMs are no exception to these precepts. Thus, wholly rhabdoid MMs may be encountered in some cases, whereas other pleural mesotheliomas may show an “ordinary” morphotype that is admixed with ERTs.161,162
Rhabdoid cells are characterized by a moderately pleomorphic epithelioid shape, eccentric nuclei with vesicular chromatin and prominent nucleoli, and distinctive eosinophilic cytoplasm having a hard globular quality (Fig. 20-35). They are relatively dyshesive; occasional spindle cell change and multinucleation may be seen as well.
Classic rhabdoid tumors of the kidney and nervous systems show consistent loss of the intranuclear INI1 gene product, which functions as a tumor suppressor.163 However, composite rhabdoid lesions generally retain it. To date, no published studies have addressed the INI1 status of rhabdoid MM.
The principal significance of a rhabdoid phenotype is the biologic aggressiveness with which it is associated, regardless of other clinicopathologic details of the individual tumor.160,162 Nonetheless, because mesotheliomas as a group have such an adverse outcome, the behavioral impact of rhabdoid change is not as great in this particular context.
Localized (Solitary) Mesothelioma
Localized MM of the pleura is defined by its gross characteristics rather than its microscopic ones. This tumor can show any of the histologic patterns considered previously (i.e., epithelioid, biphasic, sarcomatoid, and variations thereof).54,112,164,165 In contrast to diffuse pleural mesotheliomas, an increasingly spindle cell composition does not appear to affect the prognosis of people with localized MMs negatively.112,166 Insufficient numbers of these MMs have been analyzed to say with any certainty that they may be causally related to above-background asbestos exposures.
Histochemical Features of Pleural Mesothelioma
Up until 20 years ago, the separation of MMs from other histologically similar neoplasms was based largely on histochemical results. The capacity for adenocarcinomas to synthesize epithelial mucin (Fig. 20-36) had been recognized quickly after the application of specialized biochemical methods in surgical pathology, and it was soon recognized that mesotheliomas did not possess this ability.167–174 Conversely, MMs were found to manufacture stromal mucin, which was labeled by the colloidal iron or Alcian blue methods at pH 2.5, and prior treatment of tissue sections with hyaluronidase removed this substance167,170,173,175 (Fig. 20-37). Thus, these observations set the stage for the use of the periodic acid/Schiff technique, with and without diastase predigestion (to remove glycogen, which, like epithelial mucin, is positive for periodic acid/Schiff); the mucicarmine method (to label epithelial mucin); and the colloidal iron or Alcian blue procedures, with and without hyaluronidase pretreatment, for the histochemical delineation of adenocarcinomas and mesotheliomas.
Providing that one observes the cautions just cited, epithelioid mesotheliomas can be distinguished from carcinomas histochemically in approximately 50% of cases.149 The periodic acid/Schiff–diastase technique is the most useful for that purpose, because, at least, in our experience, it is more sensitive than the mucicarmine (Best) stain. Moreover, there have been sporadic reports of MMs that were spuriously labeled with the mucicarmine procedure, apparently because it unexpectedly recognized a form of stromal mucin.176 Pretreatment with hyaluronidase is successful in abrogating that aberrant reactivity, and therefore it should be used routinely if mucicarmine is utilized in differential diagnoses that include epithelioid MM.
In the same vein, colloidal iron and Alcian blue methods commonly label epithelial as well as stromal mucins. Hence, only those epithelioid lesions that lose their colloidal iron/Alcian blue positivity after hyaluronidase predigestion are consistent with mesothelial neoplasms.167,169–171 Again, roughly 50% of polygonal cell MMs manifest this pattern of reactivity.
During the 1980s, it was recognized that silver impregnation methods were able to label accumulations of intranuclear proteins that are associated with active transcription of nucleic acid. The silver-positive argyrophilic nucleolar organizer regions (AgNORs, or silver-stained nucleolar organizing regions) are now known to be related to double chromosomal “satellites,” chromosome polymorphisms, and structural abnormalities involving chromosomal satellite regions.177–179 Silver nitrate (in colloidal suspension) has an affinity for them, yielding a black precipitate, and discrete globular deposits of it are then visible in positive nuclei on conventional microscopy. The number of AgNORs seen in this way appears to parallel the density of quantitative markers of nucleolar protein synthesis, such as fibrillarin180 (Fig. 20-38). Several authors have confirmed the fact that MMs and carcinomas both have higher AgNOR counts per nucleus than do reactive mesothelial proliferations.181–183 Therefore, the usual application of this method is not to separate mesothelioma from adenocarcinoma but to distinguish MM from an atypical but benign mesothelial proliferation.181,182 AgNOR values in those two groups have ranged from slightly greater than 1 in minimally atypical benign mesothelial cells to greater than 7.5 in highly anaplastic mesothelioma cells, usually showing a bimodal distribution in mesotheliosis and MM.184 Despite the hopeful nature of these results, substantial numerical overlap still exists between the two lesional groups in question. Some have successfully used these results in combination with immunohistochemistry, image cytometry, and in situ hybridization assessment of chromosome 9p21 deletions to allow for greater than 95% accurate separation of reactive from neoplastic mesothelial proliferations.185,186
Electron Microscopic Features of Pleural Mesothelioma
In the early 1970s, several investigators began to catalog the ultrastructural characteristics of MM and compare them with those of histologically similar neoplasms.187–189 Through the ensuing years, it has become apparent that transmission electron microscopy is an extremely effective tool in the delineation of mesothelial differentiation. In addition, it provides valuable information in the differential diagnosis of other malignancies.190,191
In epithelioid mesotheliomas, a constellation of findings that includes abundant tangles of cytoplasmic intermediate filaments, with focal formation of perinuclear tonofibrils; elongated and complex desmosomes (Fig. 20-39); an absence of mucin droplets; and the presence of long, branching, plasmalemmal microvilli (with a length-to-diameter ratio of 10:1 or more)190–194 (Fig. 20-40) is typical. Other common findings include cytoplasmic glycogen deposits, dilated intercellular spaces, and intracellular lumina, which are also often lined by microvilli. External microvillous projections are sometimes difficult to evaluate with regard to their dimensions, because they can be compressed and distorted when caught between adjacent tumor cells. Basal laminae are also present around many of the neoplastic cells in mesotheliomas, and the microvilli are often coated by an amorphous granular material195,196 (Fig. 20-41).
Figure 20-40 A to C, Elongated and “bushy” plasmalemmal microvilli are seen in these epithelioid mesotheliomas ultrastructurally.
Relatively few neoplasms show all of the “classic” characteristics of MM,195 but most mesothelial tumors manifest enough of them to make their identification straightforward. In contrast, metastatic adenocarcinomas (MACs) of various anatomic origins, which represent the principal diagnostic alternative to MM, exhibit short truncated microvilli and an absence of tonofibrils and may contain intracytoplasmic mucin granules as well.190,197–199 Wick and colleagues174 performed a comparative study of electron microscopy and immunohistology in the distinction between EMMs and MACs, and they found the two techniques to be comparable in efficacy.
On the other hand, SMMs lose the distinctive plasmalemmal modifications that characterize their epithelioid counterparts. Spindle cell and pleomorphic mesotheliomas most closely resemble true sarcomas at an ultrastructural level (Fig. 20-42), except for the presence of rare intercellular junctional complexes and intermediate filament bundles.122,193,200,201 In that specific context, electron microscopic assessment is not definitive diagnostically.
Some authors have suggested that ultrastructural studies no longer add substantively to the diagnosis of MM.202 However, other authors203,204 (and those of this chapter) do not agree.
Immunohistochemical Findings in Pleural Mesothelioma
Among these problems, the one that is most commonly encountered is that of mesothelioma versus metastatic carcinoma. Despite the more uncommon nature of SMM, immunohistochemistry is nonetheless equally useful in its distinction from true sarcomas affecting the pleural space. However, in the remaining settings, in which the differential diagnosis involves a benign or reactive condition, the practical contribution of immunophenotyping is much more limited. With specific reference to desmoplastic mesothelioma, it has been properly suggested that because of its poor prognosis and the lack of effective treatment, underdiagnosis of that tumor is preferable to overdiagnosis.153 It may well take several biopsies to establish a definitive interpretation in such cases.
Each of the previously cited diagnostic questions is associated with differing panels of immunohistochemical reagents. For instance, in cases of possible spindle cell or desmoplastic mesothelioma, immunohistologic evaluation should principally focus on whether the tumor is keratin-positive. Calretinin, Wilms tumor 1 (WT1) gene product, and podoplanin have much lower rates of reactivity in SMMs compared with epithelioid and biphasic variants. Other markers, such as desmin, muscle-specific actin, and S-100 protein, are necessary only to subtype a mesenchymal neoplasm if the keratin reaction is negative. In the morphologic context of sarcoma-like tumors, the application of antibodies that are used to recognize overtly epithelial tumors (e.g., Ber-Ep4, CD15, cancer antigen 72-4 [CA 72-4], and carcinoembryonic antigen [CEA]) is illogical, because neither sarcomas nor sarcomatoid carcinomas synthesize the targets of these reagents.205 The following sections will review the different analytes that have been tested clinically in the study of MM, to provide a guide for a practical approach to immunohistochemical analysis.
Antibodies Often Used in the Analysis of Possible Mesothelioma
General and Exclusionary Markers
Keratins
Keratin antibodies have been extensively applied to MMs and their simulators, with the principal goal of distinguishing mesothelioma from adenocarcinomas206–211 and true sarcomas. Some authors have concluded that particular staining patterns for specific keratins may allow for the separation of those tumor types, and differing degrees of contextual specificity and sensitivity have been ascribed to various keratin subsets. In particular, antibodies to keratin 5/6 have been promoted as helpful immunohistochemical markers for MM211 (Fig. 20-43). In one assessment, Ordóñez found that 40 examples of mesothelioma were positive for keratin 5/6, whereas 30 pulmonary adenocarcinomas were negative. However, he also observed focal reactivity in 14 of 93 cases of nonpulmonary adenocarcinoma, to some extent limiting the utility of keratin 5/6 in the exclusion of metastases to the pleura.211 Another study reported 92% keratin 5/6 positivity in MM and 14% labeling in cases of MAC.212 Despite these drawbacks, keratin 5/6 does appear to be a helpful presumptive marker for mesothelioma when used in the proper fashion and the appropriate morphologic setting.
In general, it has been noted that reagents against high-molecular-weight keratins will label most mesotheliomas and relatively few adenocarcinomas, whereas antibodies to low-molecular-weight keratins recognize both of those tumor groups.213 Keratins 7, 8, 18, and 19 are present in all MMs and adenocarcinomas, whereas keratins 5, 6, 14, and 17 are found in some types of mesothelioma but are lacking in MACs.213 The latter four proteins are absent in cases of sarcomatoid mesothelioma.
Our approach to keratin testing in evaluating poorly differentiated malignancies is to use a broadly active mixture of monoclonal antibodies to such proteins. At present, we use a “cocktail” of commercial antibody reagents that targets all of the known keratin subtypes between keratins 1 and 20, mixed together in the same diluent and used with epitope-retrieval techniques.214 The goal of this practice is to detect any keratin, rather than a specific one, because the pragmatic task in virtually all cases is the separation of epithelial from nonepithelial malignant neoplasms. With these remarks as a preface, the sensitivity of keratin “cocktail” staining for all forms of mesothelioma (including SMM) approximates 100% in our hands (Fig. 20-44).
Epithelial Membrane Antigen
Studies dealing with anti–epithelial membrane antigen (EMA) have shown that it commonly yields positive results in both MACs and MMs.215–217 Antibodies to EMA potentially label mesotheliomas of all histologic subtypes. It has been said that this protein generally shows a double-density (“tram track”) cell membranous pattern of staining in MMs (Fig. 20-45), whereas MAC cells demonstrate more delicate membrane labeling.218 Other authors have found that reactive mesothelial hyperplasia is EMA-negative, in contrast with primary malignancies of the serosal surfaces.219 However, both of those claims are open to question220; in practical usage, we have found that the reactivity patterns in question are not universally present as depicted in the literature.
Carcinoembryonic Antigen
CEA has been considered by most observers to be one of the most reliable markers for distinguishing MM from adenocarcinoma.174,221–223 The vast majority of mesotheliomas lack CEA. Positivity for CEA has been reported in up to 5% of cases of MMs, but studies describing that phenomenon have generally used unabsorbed heteroantisera to CEA that undoubtedly recognized unrelated molecules. Monoclonal antibodies to specific CEA epitopes are more reliable in this context, although they are less sensitive for the diagnosis of adenocarcinoma and, therefore, less helpful diagnostically. However, the use of anti-CEA reagents has no role in the diagnosis of sarcomatoid mesotheliomas, as mentioned earlier.
Thyroid Transcription Factor-1
Thyroid transcription factor-1 (TTF-1) is a 38-kDa intranuclear polypeptide that is synthesized by a gene located on chromosome 14q13; it is also known as NKX2A protein. 224,225 Among epithelial elements, this homeodomain-containing nuclear transcription factor is restricted to follicular and parafollicular thyroid cells, glandular and alveolar-lining cells of the lung, and anterior pituicytes. TTF-1–positive neoplasms are largely encompassed by those same tissues, with the addition of moderately and poorly differentiated neuroendocrine carcinomas of various organs and the omission of parathyroid and pituitary tumors.224 Approximately 75% to 85% of pulmonary adenocarcinomas and adenosquamous carcinomas are labeled for TTF-1.226,227 In contrast, mesotheliomas of all histologic types have been consistently nonreactive.228 It is important to require that nuclear labeling be regarded as the only true pattern of positivity for TTF-1.229
Napsin-A
Napsin-A is a cytoplasmic aspartic proteinase that plays a role in the synthesis of surfactant protein-B in the lungs. In normal tissues, it is expressed strongly in type 2 pneumocytes. Antibodies to napsin-A have been applied clinically only recently, and the overall number of mesotheliomas and adenocarcinomas studied thus far is relatively small. However, in one evaluation, 85% of pulmonary adenocarcinomas were napsin-A–reactive, compared with no cases of mesothelioma or colonic, pancreatic, or mammary carcinoma.230 Unexpectedly, napsin-A was also observed in clear cell and papillary renal cell carcinomas (RCCs), as well as in tall cell papillary thyroid carcinomas. It appears that this marker may best be used in the narrow differential diagnosis of peripheral pulmonary adenocarcinoma versus EMM.
CD15
CD15 has a high level of specificity for MACs,174,222,223,231–233 but some examples of MM have also shown focal labeling for this marker. This finding appears to be more common in peritoneal tumors than in pleural lesions.234 Like CEA, the use of CD15 is most appropriate in the evaluation of biphasic or epithelial mesotheliomas, because sarcomatoid tumors consistently lack it.
CA 72-4
CA 72-4, which is also known as tumor-associated glycoprotein-72 (recognized by monoclonal antibody B72.3), is a generic epithelial determinant that is a high-molecular-weight cell membranous glycoprotein.234–239 Regardless of their sites of origin, the majority of MACs show strong reactivity for this marker. Rare examples of MM may also show focal or weak labeling.240
Ber-Ep4
Ber-Ep4 is another epithelial marker that was initially thought to be specific for adenocarcinomas,241,242 and it does indeed demonstrate a high level of sensitivity for these neoplasms as a generic group. Nevertheless, it is now known that approximately 15% of mesotheliomas can show focal staining with this antibody,243,244 and it has no value in the evaluation of purely sarcomatoid tumors.
MOC-31
MOC-31 is a monoclonal antibody that labels a 35-kDa transmembrane glycoprotein in the plasmalemma of most glandular cells.245,246 This molecule is closely related to lung cancer–associated antigen-2,247 but, in addition to pulmonary adenocarcinomas, MOC-31 is reactive with glandular malignancies arising in most other organ sites as well.248,249 Mesotheliomas are reproducibly negative for this marker.244,249
BG8
BG8 is a synonym for Lewis blood group antigen Y (Ley; CD174), a glycoprotein that is overrepresented in malignant epithelium and is again widely distributed in glandular cells throughout the body.250–252 Accordingly, its immunohistochemical characteristics in neoplasia generally parallel those of the MOC-31 antigen.228,253
p53
The p53 gene product is a nuclear phosphoprotein that regulates DNA replication, cell proliferation, and apoptosis.254 In cases featuring atypical spindle cell proliferations that are morphologically suspicious for DMM, p53 immunolabeling of greater than 10% of the lesional cells favors a diagnosis of mesothelioma over one of a cellular pleural plaque or fibrohyaline pleuritis.224 Nevertheless, that characteristic is not observed in all DMMs, and all cases of pleuritis are not necessarily p53-negative.
Another salient observation is that mutant p53 proteins, which are generally recognized by immunohistologic studies, are relatively restricted to MMs and are not typically seen in resting or reactive mesothelial cells.255–258 On the face of things, mutant p53 therefore would seem to have potential value in the distinction of cytologically bland MM from mesothelial hyperplasia. Nevertheless, we would suggest avoiding exclusive reliance on p53 under such circumstances based on their clinical experience with this problem. They have seen several examples of undeniably benign mesothelial proliferations that were unexpectedly immunoreactive for p53.
Inclusionary Markers
The aforementioned antibodies include several that have been recommended by the U.S. and Canadian Mesothelioma Panel,173 and they are probably the most commonly used markers in surgical pathology laboratories for the evaluation of malignant pleural neoplasms. However, except for p53, all of the markers presented thus far assist in the diagnosis of MM by exclusion. Over the past several years, efforts have been directed at identifying “proactive” markers of mesothelioma (i.e., those that would be present in the majority of MMs). Some such antibodies have been used diagnostically, whereas others have been analyzed as prognostic indicators. A brief discussion of these reagents follows.
Calretinin
Calretinin is a member of a large family of cytoplasmic calcium-binding proteins.259 This marker is seen in more than 95% of mesothelioma cases of the epithelioid and biphasic types260–262 (Fig. 20-46). Antibodies to other related polypeptides are also available, including antiparvalbumin and anticalbindin, but they fail to recognize mesotheliomas and non-neoplastic mesothelium.263 Interestingly, there are conflicting reports regarding the expression of calretinin in sarcomatoid mesothelioma; some observers have seen universal staining of such neoplasms, but others have claimed that they are negative.264–266 Our experience is that approximately 30% to 40% of sarcomatoid lesions do, in fact, label for calretinin, albeit in a focal fashion. Selected studies have shown that this antibody may also stain some adenocarcinomas,261 but, if one requires nuclear labeling for calretinin as a truly positive result, these are few in number.
WT1 Gene Product
The WT1 gene resides on the short arm of chromosome 11. When it is deleted constitutively, patients have a tendency to develop nephroblastoma, an embryonal renal tumor.267 Because of this association, WT1 has generally been regarded as a tumor-suppressor gene, but it is conversely overexpressed in other malignancies, including mesothelioma, and therefore also may function as an oncogene.268 Nuclear immunolabeling for WT1 gene product is apparent in greater than 80% of epithelioid and biphasic MMs (Fig. 20-47), but sarcomatoid tumors again demonstrate lesser reactivity in approximately 30% of cases.228,244,265,266,269–271 WT1 is not restricted to mesothelial proliferations, and is also present in carcinomas of the thyroid, kidney, ovaries, and endometrium, some of which enter into differential diagnosis with MM.272,273 Because it is typically absent in adenocarcinoma of the lung, WT1 has greatest applicability when this tumor is the principal diagnostic alternative to epithelioid mesothelioma.228 Its use in the analysis of sarcomatoid tumors is complicated by the fact that true sarcomas can also be WT1-positive.274
Figure 20-47 Nuclear immunolabeling for WT1 protein in epithelioid (A) and sarcomatoid (B) mesotheliomas.
In a comparison of two monoclonal antibodies to WT1, clone WT49 and clone 6F-H2, Tsuta and associates275 found that the first reagent demonstrated greater sensitivity for mesothelioma but it also labeled a higher number of nonmesothelial malignancies, including some lung carcinomas and synovial sarcomas.
Thrombomodulin
Thrombomodulin, or CD141, converts thrombin from a procoagulant protease to an anticoagulant.276 It is found in endothelial cells, syncytiotrophoblasts, mesothelia, and various epithelia, principally including squamous and transitional cells.277,278 The majority of MMs (approximately 65%) label for CD141,212,222,244,253,262,279 (Fig. 20-48) as well as squamous cell carcinomas and transitional cell carcinomas.231,249 Fortunately, p63 protein-immunoreactivity can be used to recognize the latter two tumors, because mesotheliomas are p63-negative.280 Glandular malignancies of various origins (including the lung) have also demonstrated unexpected reactivity in some series, and as many as 13% of adenocarcinomas have been positive.261 Epithelioid hemangioendotheliomas and angiosarcomas, which may occasionally enter differential diagnosis with mesothelioma, are also potentially immunoreactive for CD141.281
Podoplanin
Podoplanin, also known as T1-alpha and Aggrus and recognized by monoclonal antibody D2-40, is a mucin-type transmembrane glycoprotein with extensive O-glycosylation. It was first identified in podocytes of the renal glomerulus.282 This protein is specifically seen in lymphatic endothelial cells but not in vascular endothelia. In addition, nonendothelial cells in various normal tissues and human neoplasms (seminoma, Kaposi sarcoma, dendritic cell tumors, adrenocortical tumors, adnexal neoplasms of the skin, chondrosarcoma, thymoma, squamous carcinomas, meningioma, solitary fibrous tumor, and others) also express podoplanin.283–287 The principal functions of this protein in normal tissues center on the promotion of lymphatic vasogenesis, podocyte shaping, and platelet aggregation.283
Several studies284,288–292 have shown that podoplanin is a reasonably effective “proactive” marker for mesothelioma (Fig. 20-49). Conversely, it is typically, but not always, absent in carcinomas of the lung and breast.288,292,293 Padgett and coworkers294 reported that podoplanin was a better marker for SMM than calretinin, but 30% of sarcomatoid mesothelial tumors were still podoplanin-negative in that evaluation. We and others290 believe that this analyte is best used in combination with either calretinin or WT1, as a second-tier marker for mesothelioma.
Other Markers
Oncofetal Proteins
The use of antibodies to oncofetal proteins is most commonly undertaken in the study of germ cell tumors. However, their role in the differential diagnosis of mesothelioma has been assessed in a few studies. Beta-human chorionic gonadotropin, pregnancy-specific glycoprotein, human placental lactogen, and placenta-like alkaline phosphatase have been principally found in adenocarcinomas of various sites.295 However, the sensitivity of these determinants is relatively low, and some examples of human chorionic gonadotropin production by pleural mesotheliomas have indeed been described.296
Blood Group Isoantigens
In addition to Lewis blood group antigens, as typified by BG8 (see previous discussion), some studies have compared the relative reactivities of MM and adenocarcinomas for blood group isoantigens A, B, and H.174,250,297 Their staining patterns generally mirror those of BG8, being restricted to carcinomas, but with lesser sensitivity.
Mesothelin
Mesothelin is a 40-kDa plasmalemmal protein that may function in intercellular adhesion. It is seen in roughly 70% of epithelioid and biphasic MMs, but sarcomatoid mesothelial tumors are negative.298 Controversy has surrounded the differential diagnostic specificity of this marker vis-à-vis mesothelioma, and recent studies have reported mesothelin reactivity in a broad range of carcinomas as well.299
HBME-1 and Cancer Antigen 125
HBME-1 is a monoclonal antibody that was raised against mesothelial cells, and it recognizes a membranous glycoprotein. Although it demonstrates a high degree of sensitivity for MM249,271,279 (Fig. 20-50), several studies over the past decade have shown that it clearly is not a mesothelium-specific reagent. Adenocarcinomas of several sites, including the lung, kidney, thyroid, and female genital tract, are also potentially HBME-1–reactive.244,300–302 Similar comments apply to another mesothelium-related marker, OC125 (recognized by the monoclonal antibody cancer antigen 125 [CA 125])302; in fact, that determinant is widely used to label müllerian carcinomas.303
Neuroendocrine Determinants
Small cell MM may be confused with metastatic neuroendocrine carcinoma in the pleura. With that in mind, it is noteworthy that small cell mesotheliomas commonly manifest immunoreactivity for determinants that are generally regarded as neuroendocrine markers: namely, neuron-specific (gamma-dimer) enolase and CD57.304 However, more specific indicators of a neuroendocrine lineage, such as chromogranin-A, CD56, and synaptophysin, are absent in MMs, and these tumors also lack the paranuclear “dotlike” staining for keratin that is seen in small cell carcinomas.
Additional Hematopoietic Markers
CD15 and CD141 have already been discussed with reference to their relative presence in mesothelial tumors. Other hematopoietic markers of interest in this setting include CD10 (neutral endopeptidase; common acute lymphoblastic leukemia antigen) and CD138 (syndecan-1). Among epithelial malignancies, CD10 is most commonly used as a potential indicator for RCC and hepatocellular carcinoma (HCC),305,306 and pleural metastases of these tumors can certainly imitate MM morphologically. Unfortunately, mesotheliomas may also express CD10,307 making it necessary to rely on additional discriminants in this context. On the other hand, CD138 is seen in a variety of carcinomas (e.g., pulmonary, colonic, pancreaticobiliary, hepatocellular, prostatic, renal, transitional cell, mammary, ovarian, endometrial, cutaneous, thyroid, adrenal, and salivary glandular) in differing percentages (Fig. 20-51). MM is consistently CD138-negative.308
Other Supplementary Reagents
Several other antibodies have been applied to the identification of EMMs in the past, and more are likely to appear in the future. For the most part, those that have not been mentioned specifically in this review are not considered to be standard diagnostic markers. However, for purposes of completeness, their relative reactivity patterns in epithelioid mesotheliomas and MACs are provided in Table 20-1 (see also Table 16-1).309–317
Table 20-1 Supplementary Immunohistochemical Reagents Used to Distinguish Epithelioid Mesothelioma from Adenocarcinoma*
| Marker | Mesothelioma† | Adenocarcinomas |
|---|---|---|
| Desmin | ± 37% | — |
| HMFG-2 | ± 15% | ± 75% |
| N-Cadherin | + 73% | ± 30% |
| CD44S | + 73% | ± 48% |
| LN1 | ± 48% | + 86% |
| CD56 | — | ± 16% |
| LN2 | ± 5% | + 91% |
| p21 ras | ± 13% | ± 16% |
| XIAP | ± 80% | ± 50% |
| IMP3 | ± 90% | ± 75% |
| TEN-X | ± 90% | ± 23% |
| PAX2 | ± 4% | ± 65% (Müllerian carcinomas) |
| PAX8 | ± 9% | ± 95% (Müllerian carcinomas) |
| CA 19-9 | ± 20% | ± 70% |
HMFG-2, human milk fat globule protein-2; IMP3, insulin-like growth factor-2 messenger RNA (mRNA)-binding protein-3; PAX, paired box gene; TEN-X, tenascin-X; XIAP, X-linked inhibitor of apoptosis protein.
* See also text and Table 16-1.
† Percentages are derived from a synthesis of the pertinent literature (also see references 309–317).
Practical Points Regarding the Immunohistochemistry of Mesothelioma
In a critical review of the numerous publications on the immunohistochemistry of MMs, one sees proof of the general tenet that single immunostains cannot be used to establish any given diagnosis with certainty. It is therefore desirable that a panel of reagents be used, including at least two carefully chosen discriminatory antibodies “for” and “against” a diagnosis of mesothelioma.318
Other authors have suggested that the proportion of mesotheliomas that can be recognized confidently increases in direct proportion to the number of antibodies used.253,319 In contrast, Ordoñez244 has recommended that
Using logic regression analysis of 12 markers, Yaziji and colleagues concluded that a 3-marker panel (calretinin, MOC31, and BG8) was diagnostically sufficient and accurate in separating adenocarcinoma from EMM.320 Marchevsky and Wick, Kushitani and associates, and King and coworkers have reached similar conclusions.309,321,322 Thus, we see no practical need to use an exhaustive list of antibody reagents323 in this particular setting.
Cytogenetic and Molecular Features of Pleural Mesothelioma
Cytogenetic studies on human MMs have shown no consistent chromosomal abnormalities.324 Of those that have been reported, several appear to be relatively random events: monosomy 6; assorted trisomies and polysomies; allelic losses of 4p and 4q; deletions of 1p22, 3p, 7q, and 14q; and complete loss of chromosomes 21, 22, and Y.325–331 On the other hand, a relatively consistent deletion of 9p21-22, involving the CDKN2A/INK4A gene, has been seen in up to 60% of cases in some studies.332–335
Mutations in the p53 gene have received substantial attention as possible differential diagnostic tools in mesothelial proliferations.255,258,336–340 However, MM does not inevitably manifest such abnormalities, and they have been reported in 33% to 70% of cases in various series.258,338,340 Point mutations also may occur in the INK4A gene.341
On the other hand, several genes and their protein products may be overexpressed in mesothelioma. They include those coding for platelet-derived growth factors, hepatocyte growth factor, c-met, insulin-like growth factor-1, transforming growth factor-beta, bcl-2, mitogen- activated protein kinase, and phosphatidylinositol-3-kinase.342–347 HER-2/c-erbB-2, epidermal growth factor receptor, and K-ras genes are not altered in MM.347,348 Interestingly, Ramos-Nino and colleagues have suggested that the activator protein-1 gene complex, encoding transcription factors such as c-fos, Fos-B, Fra-1, Fra-2, c-jun, Jun-B, and Jun-D, is activated in those mesotheliomas that are etiologically related to asbestos.349
Differential Diagnosis of Pleural Mesothelioma: Special Considerations
Differential Diagnosis of Benign versus Malignant Mesothelial Proliferations
Florid Mesothelial Hyperplasia versus Epithelioid Mesothelioma
Mesothelial hyperplasia seen in the context of infectious or inflammatory pleural effusions can be exuberant and moderately atypical cytologically (Fig. 20-52). Especially when the mesothelium becomes entrapped in organizing fibrinous exudates, histologic images in pleural biopsies may engender serious concern over the possibility of EMM.
Differential diagnosis centers on the presence of actual invasion by the proliferation in question, and this can be identified only in an adequate tissue sample. If a deep enough portion of pleura is obtained, one can usually see a zonal phenomenon in mesothelial hyperplasia, wherein the cellularity of the tissue decreases with increasing distance from the pleural surface, and no mesothelial aggregates are visualized in the pleural fibroadipose tissue.156,157 Otherwise, the superficial portions of such specimens may be markedly cellular, even with formation of micropapillary structures that are mantled by atypical mesothelial cells.
As stated above, we are not strong proponents of reliance on immunohistochemical studies in this setting. It has been suggested by others that strong labeling for EMA and p53 protein in the proliferating mesothelium is an indicator of malignancy.215,218,219,257,350 However, we have observed several cases in which both of those markers were unequivocally present in mesothelial proliferations that proved to be benign.
Hopeful assertions also have been made regarding the use of X-linked inhibitor of apoptosis protein (XIAP) and the glucose transporter-1 isoform as discriminants of benign and malignant mesothelial proliferations.351,352 Nonetheless, differences of opinion have been advanced regarding the relative merits of these markers.351
Another intriguing recent publication concerns the use of cyclin-dependent kinase inhibitor-2A (CDKN2A; INK4A; p16) in this setting. That moiety inhibits cyclin-dependent kinase-4 and is encoded by a gene on chromosome 9p21. Using fluorescence in situ hybridization and ThinPrep cytologic preparations of pleural effusion specimens, Illei and associates found that mesotheliomas exhibited homozygous deletion for CDKN2A, whereas reactive benign mesothelium showed retention of at least one copy of the gene.353
Fibrohyaline Pleuritis versus Desmoplastic Mesothelioma
One of the most difficult problems confronting thoracic surgeons and surgical pathologists is the patient who has had a long-standing or recurrent pleural effusion, culminating in a “rind” of organized and densely collagenized tissue that obliterates the pleural space and encompasses the lung. Under these circumstances, the diagnostic alternatives are those of fibrohyaline pleuritis (fibrous pleurisy) and DMM. The distinction between these conditions can be challenging even with a complete pleurectomy specimen in hand, but sufficient sampling is again the key to proper diagnosis. Criteria that are used for recognition of DMM include foci of necrosis, obvious invasion of pleural adipose tissue or subjacent lung, and the presence of obvious focal cellular anaplasia.153,154 p53 immunostaining has again been used by some authors in this context,354 but results of this analysis are similar conceptually to those attending the evaluation of mesothelial hyperplasia, as discussed above.
Differential Diagnosis of Cytologically Malignant Pleural Neoplasms
Epithelioid Mesothelioma versus Hematopoietic Malignancies
Uncommonly, hematopoietic malignancies such as large cell non-Hodgkin lymphoma, syncytial or “sarcomatoid” Hodgkin lymphoma, granulocytic sarcoma (tumefactive acute myelogenous leukemia), and plasmacytic myeloma may be primary neoplasms of the pleura and simulate MM, both clinically and morphologically (Fig. 20-53).355–359 These tumors are constituted by large polygonal or round cells, like EMM, and their histologic images are accordingly very similar to that of the solid-anaplastic variety of mesothelioma. Hematopoietic malignancies demonstrate a much more notable degree of apoptosis than that seen in MM, with greater irregularity in the nuclear contours of the tumor cells and more numerous mitoses (Fig. 20-54). Electron microscopic analysis fails to show any intercellular attachment complexes in such lesions, in contrast to their prominence in MMs; similarly, plasmalemmal microvilli are absent in lymphoma and leukemia. Parenthetically, there is a form of large cell non-Hodgkin lymphoma, known as anemone cell lymphoma, in which numerous cell-surface projections are evident,360 but these structures are not true microvilli.
Immunohistologic studies reveal a lack of keratin and calretinin in hematopoietic tumors, which instead exhibit variable reactivity for CD15, CD20, CD43, CD45, and CD138.359,361 However, CD30 and the WT1 gene product may be reactive in mesothelioma as well as in hematopoietic malignancies.362,363 The latter marker is particularly prevalent in granulocytic sarcoma.
Epithelioid Mesothelioma versus Epithelioid Endothelial Neoplasms
Epithelioid mesothelioma may exhibit cytoplasmic macrovacuolation, a feature also common to epithelioid vascular tumors such as epithelioid hemangioendothelioma (EHE) and epithelioid angiosarcoma (EAS), both of which can represent primary pleural neoplasms111,364–368 (Fig. 20-55).
Ultrastructural studies are usually definitive in separating EMM from EHE and EAS. MM shows elaborate microvillous differentiation, complex desmosomes, and cytoplasmic tonofibrils, none of which is apparent in vascular lesions. On the other hand, the cells of EHE and EAS contain variable numbers of Weibel-Palade bodies, which are elongated, tubular, electron-dense cytoplasmic structures with internal striations.369,370
Immunohistologically, epithelioid vascular tumors are unusual mesenchymal neoplasms because they rather commonly exhibit an “aberrant” expression of keratin.371 They are also reactive for CD141281 as are mesothelial proliferations. However, EHE and EAS lack calretinin, WT1 protein, and keratin 5/6, and instead, EHE and EAS are consistently positive for CD31, FLI-1, and CD34372,373 (Fig. 20-56). All of the latter markers are absent in mesotheliomas.
Primary Pleural Myxoid Chondrosarcoma versus Mesothelioma
Extraskeletal myxoid chondrosarcoma (EMC) is a soft tissue tumor that is cytogenetically characterized by two chromosomal translocations, t(9;22)(q22;q11-12) and t(9;17)(q22;q11), which yield the EWS/CHN or RBP56/CHN fusion genes, respectively.374 It has rarely been reported as a primary pleural malignancy,375 and its histologic image may simulate that of epithelioid mesothelioma. However, EMC lacks the microvillous plasmalemmal differentiation of MM on electron microscopy, and instead it shows the presence of cytoplasmic intrareticular microtubules (Fig. 20-57). It is also consistently nonreactive for keratin and calretinin, instead labeling for vimentin and variably for S-100 protein, neuron-specific enolase, and protein gene product 9.5,376,377 none of which is seen in mesotheliomas. On the other hand, stains for podoplanin may be positive in both EMC and MM.378 The characteristic fusion gene proteins of EMC can also be demonstrated rapidly using the polymerase chain reaction,374 and they are consistently lacking in mesothelial tumors.
Synovial Sarcoma versus Mesothelioma
The clinicopathologic characteristics of pleuropulmonary synovial sarcoma have been provided in Chapter 14, including the potential for that tumor to mimic biphasic or sarcomatoid mesotheliomas379 (Fig. 20-58). Specialized pathologic studies are most productive in biphasic tumors, where the microvillous ultrastructural nature of epithelioid cells in MM is not reproduced in synovial sarcoma.380 Additionally, biphasic synovial sarcoma often manifests Ber-Ep4 reactivity, occasionally CD141, and fails to express WT1 in its epithelioid elements.381 Mesotheliomas usually demonstrate the converse of that profile. Diffuse expression of keratins 7 and 19 in mesotheliomas also contrasts with focal labeling for these proteins in synovial sarcoma, whereas keratin 14 may be seen in synovial sarcoma, but not most mesotheliomas. Calretinin and podoplanin are potentially common to both monophasic spindle cell synovial sarcoma and purely sarcomatoid mesothelioma, but WT1 protein is only encountered in MMs. Nuclear immunolabeling for TLE1 is a consistent finding in synovial sarcoma382; to date, there have been no systematic studies addressing the presence or absence of this marker in sarcomatoid mesothelioma.
Ultimately, molecular analysis may be necessary to establish a definitive interpretation in this setting. Virtually all synovial sarcomas show a reproducible t(X;18) chromosomal translocation, which is not seen in MMs. Its presence can be assessed indirectly by using the polymerase chain reaction with primers designed to identify the SYT–SSX1 and SYT–SSX2 fusion proteins that are produced by the translocation in question.383
Pseudomesotheliomatous Sarcomatoid Carcinoma versus Mesothelioma
A related morphologic problem is represented by sarcomatoid carcinomas that extensively involve the pleura and simulate mesothelioma (Fig. 20-59). These lesions may show biphasic or spindle cell/pleomorphic images, and they can originate in the lung, kidney, and breast, as well as at other sites.36 As true in biphasic synovial sarcomas, the ultrastructural and immunophenotypic attributes of epithelioid components in biphasic carcinomas are distinct from those of biphasic MMs.384 Purely nonepithelioid lesions in both categories are more difficult to separate from one another. The presence of immunoreactivity for calretinin and WT1 favors mesothelioma, in our experience, but other authors have come to different conclusions.293
From the perspective of patient management, this diagnostic distinction is not crucial, because pseudomesotheliomatous carcinomas and mesotheliomas generally manifest the same limited response to therapy and a comparably adverse prognosis.34–36 However, medicolegal issues attending the two neoplasms are potentially quite different.
Small Cell Mesothelioma versus Other Small Cell Malignancies
In limited biopsy specimens, small cell mesothelioma may be difficult to distinguish from metastatic small cell neuroendocrine carcinoma (SCNC) involving the pleura385 or from Askin tumor (primary thoracopulmonary primitive neuroectodermal tumor; PNET). The latter two lesions have been considered in more detail in Chapters 13 and 14. To date, ultrastructural studies on small cell MM have not been performed; hence, it is not known whether it shares the microvillous electron microscopic attributes of conventional epithelioid mesotheliomas, or, alternatively, manifests the formation of blunt neuritic-type cytoplasmic extensions as seen in PNET. Immunohistologically, all three lesions in this differential diagnostic cluster may exhibit reactivity for pankeratin; however, as mentioned earlier, SCNC tends to show distinctive globules of paranuclear keratin reactivity that are not shared by MM or PNET321 (Fig. 20-60). Moreover, keratin 5/6 and calretinin are more often observed in small cell MM than in SCNC,231 and they have not been reported in Askin tumor. Other helpful determinants for the separation of such lesions are hematopoietic in nature. CD99 is unique to PNET in this group, CD56 and CD57 are seen in SCNC and PNET but not small cell MM, and CD141 is seen in mesothelioma but tends to be absent in the other neoplasms.261,386 Metastatic small cell carcinoma of the lung is characteristically positive for the markers MOC-31 and anti–TTF-1,387,388 whereas MM and Askin tumor are negative for these markers.
Primary Pleural Thymomatosis versus Mesothelioma
The capability for thymomas to arise and spread in the pleura, simulating mesothelioma clinicopathologically,389 is discussed in Chapter 19. To reiterate, although both of these tumors share potential immunoreactivity for keratin 5/6, thrombomodulin, and calretinin, only thymomas contain lymphoid cells that express CD1a, terminal deoxynucleotidyl-transferase, and CD99, and epithelial cells that are labeled for p63 protein.390 Lastly, microvilli are not evident in thymic epithelial neoplasms ultrastructurally.391
Solitary Fibrous Tumor of the Pleura versus Sarcomatoid Mesothelioma
When provided only with small biopsy specimens and given no clinical information, pathologists may conceivably confuse atypical variants of solitary fibrous tumor of the pleura with SMM on morphologic grounds. Nevertheless, the immunophenotypes of these neoplasms are mutually exclusive. Solitary fibrous tumor is reactive for CD34, with or without CD99 and bcl-2 protein, but it lacks keratin. Mesothelioma shows the opposite profile.392 Both lesions may show immunoreactivity for podoplanin.
Clear Cell Mesothelioma versus Metastatic Renal Cell Carcinoma
Clear cell mesotheliomas are rare, but they may be closely simulated by metastases of “conventional” renal cell carcinoma (RCC)393 (Fig. 20-61). The latter of these neoplasms lacks unique and easily detected markers, and, particularly because they also share potential positivity for several proteins with mesothelioma (including keratin, vimentin, CD10, WT1, and thrombomodulin),305,394 a tailored immunohistologic approach to differential diagnosis is necessary in this specific instance. The markers that are most discriminatory between RCC and clear cell MM include keratin 5/6, calretinin, CD15, Ber-Ep4, BG8, and PAX2 (Fig. 20-62). The presence of the first two determinants strongly favors an interpretation of mesothelioma, whereas positivity for any two of the other listed markers is representative of RCC.395,396
Figure 20-62 Nuclear labeling for PAX2 confirms the renal origin of the neoplasm shown in Figure 20-61.
This is a circumstance where electron microscopic study may sometimes be superior in specificity to immunohistochemical analysis. RCCs have poorly formed plasmalemmal microvilli and no cytoplasmic tonofibrils, and, instead, they contain prominent cytoplasmic collections of glycogen, or lipid, or both.397 Clear cell mesothelioma does not share those ultrastructural characteristics, because it is basically a variant of EMM.
Oncocytoid/Deciduoid Mesothelioma versus Other “Pink” Cell Malignancies
Deciduoid/oncocytoid mesothelioma can be simulated by pleural metastases of carcinomas that are constituted by large “pink” cells. These principally include HCC, adrenocortical carcinoma (ACC), and RCC.398 Electron microscopy provides valuable information in this particular context, because none of the cited tumors, except for deciduoid MM, contains elongated plasmalemmal microvilli, complex desmosomes, or tonofilaments. Moreover, ACC (and sometimes RCC) may also manifest the presence of tubulovesicular mitochondrial cristae,399 which are absent in mesotheliomas. Immunohistologic separation of such tumors centers on a few key determinants. EMA is consistently present in oncocytoid MM and RCC but is absent in HCC and ACC.400 On the other hand, keratin is paradoxically absent in paraffin sections of ACC, even though it is undeniably epithelial.401 Those two markers are particularly important in regard to the separation of MM and adrenocortical neoplasms, because both of them are commonly positive for calretinin and podoplanin.402 However, ACC also shows reactivity for inhibin (Fig. 20-63) and CD56, both of which are not seen in mesotheliomas.308 The distinction of oncocytoid RCC and MM is basically comparable to that attending their clear cell variants, as discussed previously. Lastly, an antibody known as HepPar1 is contextually selective for HCC and reproducibly allows for a distinction of this tumor from mesotheliomas.306
Rhabdoid Mesothelioma versus Metastases of Extrarenal Malignant Rhabdoid Tumors
As mentioned earlier, extrarenal malignant rhabdoid tumor is probably a phenotype as well as a neoplastic entity. In other words, a spectrum of tumor types—including mesothelioma—may undergo clonal evolution and assume a rhabdoid appearance.160,161 When that occurs, ultrastructural and immunophenotypic characteristics of the original lesion are usually lost in the rhabdoid component. Regardless of its derivation, extrarenal malignant rhabdoid tumor has the ability to show paranuclear whorls of intermediate filaments by electron microscopy (Fig. 20-64), as well as potential immunoreactivity for keratin, vimentin, desmin, EMA, actins, CD99, and WT1 protein.161 Other markers of potential mesothelial differentiation (e.g., calretinin, CD141, keratin 5/6) are absent.160 Hence, a rhabdoid mesothelioma is not concretely identifiable as such unless it also has a minor “conventional” MM component that is concurrently sampled.
Epithelioid Mesothelioma versus Primary or Metastatic Germ Cell Malignancies
Very uncommonly, malignant germ cell tumors—principally represented by embryonal carcinoma and yolk sac carcinoma, or combinations thereof—may arise primarily in the pleuropulmonary compartment.403 In addition, metastases from occult neoplasms of these types in other anatomic sites rarely can secondarily involve the pleura. Such tumors may imitate that of solid “anaplastic” MM. Electron microscopy is an effective means of separating germ cell neoplasms from mesotheliomas, because plasmalemmal microvilli are absent in the former of those tumor groups.404
Immunohistologic studies show reactivity for placental alkaline phosphatase and OCT-3/4 in germ cell tumors, with or without CD117,400,405,406 but they lack calretinin and WT1 protein. Once again, these results are incompatible with the phenotype of MM.407
Metastatic Intranodal Mesothelioma versus Lymph Nodal Mesothelial Rests
Several reports have highlighted the presence of mesothelial inclusions (rests) in the sinusoids of intrathoracic lymph nodes408–410 (Fig. 20-65). They may be found incidentally and unexpectedly in nodes that are removed in the treatment of other clinical conditions. Under such circumstances, specialized pathologic evaluations are incapable of distinguishing such benign and probably developmental abnormalities from metastatic intranodal mesothelioma. However, in all cases documented to date, the affected patients had no evidence of pleural disease, and therefore a diagnosis of MM would have been untenable. The involved nodes are frequently congested. Metastatic adenocarcinoma is another consideration under these circumstances, but that possibility can be dismissed by appropriate immunohistochemical studies, as outlined earlier.408
Borderline (Low-Grade Malignant) Mesothelial Tumors
Even though Chapter 19 is devoted to both benign and borderline neoplasms of the thorax, only pleural adenomatoid tumors are included there among mesothelial lesions. That decision was made to allow for a more unified discussion at this point of mesothelial proliferations with either low-grade malignant or obviously aggressive features. Two additional lesions with mesothelial differentiation, both of which have a limited potential for local recurrence or distant spread, are considered in the following sections. These are well-differentiated papillary mesothelioma (WDPM) and multicystic mesothelial tumor of borderline biologic potential (MMTBBP; formerly called multicystic mesothelioma).
Etiologic Considerations
Both WDPM and MMTBBP were initially described as abdominal lesions in young individuals who were typically female.411,412 They were thought to be unassociated causally with asbestos exposure, whether they occurred in the abdomen or the chest.
Few examples of pleural WDPM and MMTBBP have been described, and it would therefore be premature to draw definite conclusions on their pathogeneses. MMTBBP of the thorax has yet to be linked with any definable etiologic agent. However, Butnor and coworkers described seven examples of pleural WDPM, two of which occurred in patients with objective radiographic or pathologic evidence of above-background asbestos exposure.413 Such evidence was reflected by the presence of fibrohyaline pleural plaques. Eleven of 24 patients with pleural WDPM reported by Galateau-Sallé and colleagues also were said to have reported past occupational asbestos exposure.414 These data raise the prospect that asbestos may indeed cause some examples of pleural WDPM.
Clinical Findings
Some cases of WDPM of the pleura have presented similarly to conventional forms of epithelioid mesothelioma, with dyspnea and a serosal effusion.413–415 Radiographic assessment has shown pleural nodularity in association with an effusion.413
MMTBBP of the pleura is extraordinarily rare, with only one published example. That patient was a 37-year-old woman who presented with a localized, multiloculated intrapleural mass that was found on imaging studies. No pleural effusion was apparent.416 We have seen one other lesion of this type in a 34-year-old woman with a unilateral pleural mass.
The evolution of WDPM of the pleura has been variable; of four cases in the report by Butnor and coworkers in which follow-up was available, all of the patients were alive with persistent tumor at least 6 months after diagnosis.345 Survival averaged 74 months in the series of Galateau-Sallé and colleagues,414 compared with 9.9 months in a comparison group of paired patients with conventional pleural MM. Another female patient with pleural WDPM, reported by Kao and associates, was well after 16 years.417 None of the lesions has metastasized outside the thorax or crossed the anatomic midline. In a singular departure from that theme, Torii and coworkers reported a case of WDPM that invaded the lung, mediastinum, and chest wall.418 The single reported MMTBBP of the pleura was cured by excision,416 and the patient in our unpublished case is also free of disease after surgery.
Pathologic Observations
Pleural WDPM has manifested itself either as a multifocal nodular proliferation, with firm white-tan lesions on the serosal surface, or as a single exophytic growth that projected into the pleural space. The size of individual nodules in such cases has ranged from less than 1 to 5 cm in greatest dimension.413 These descriptions obviously overlap with the macroscopic features of conventional mesotheliomas. On the other hand, MMTBBP has a distinctive image, represented by a well-circumscribed agglomeration of thin-walled cysts filled with serous fluid (Fig. 20-66). No internal nodularity usually is apparent when the cystic cavities are opened.
Microscopically, WDPM is typified by arborescent fibrovascular papillary projections of variable width and length, which are covered by one or two layers of relatively bland cuboidal mesothelium (Fig. 20-67). Nuclei are round to oval, with vesicular or dispersed chromatin and focally prominent nucleoli, and mitotic figures are sparse.413,414 Some examples show hyalinization or fibroblastic proliferation in the papillary cores, or psammoma bodies, or combinations thereof. The supporting papillary stroma may also be mucomyxoid in character, producing a superficial resemblance to placental villi. Limited infiltration of the subjacent pleural soft tissue by tubular cell profiles is seen in a minority of cases. Histochemical, ultrastructural, and immunohistochemical attributes of WDPM are comparable to those that are associated with conventional mesothelioma morphotypes.
The multicystic mesothelial tumor histologically comprises relatively large macrocystic spaces that are bounded by hypocellular collagenized stroma and filled with lightly eosinophilic serous fluid. The cysts are mantled by a single layer of bland cuboidal mesothelial cells with “hobnail” nuclear profiles (Fig. 20-68). No nucleoli or mitotic activity is apparent, and, although tubular profiles may surround the cystic spaces, there is no infiltration of the surrounding tissue by the lesional cells.
Staging and Prognosis of Malignant Mesothelioma
In general, tumor stage is the most powerful predictor of biologic behavior for any given malignancy. Several staging systems have been used to document the locoregional and distant growth of MM. The first of these was the Butchart (English) scheme, proposed in 1976.419 It dealt descriptively with the general growth characteristics of individual tumors. That same principle was later expanded by the International Mesothelioma Interest Group420 and codified by the American Joint Committee on Cancer, in a formal tumor-node-metastasis (TNM) format.421 The Thoracic Oncology Group at the Brigham and Women’s Hospital has also advanced a pragmatic surgery-oriented staging system that has entered clinical use.422 These three schemes are summarized in Tables 20-2 and 20-3.
Table 20-2 Butchart (British) Staging System for Malignant Pleural Mesothelioma
| Stage | Location |
|---|---|
| I | Tumor confined to the ipsilateral pleura, lung, or pericardium |
| II | Tumor invading the chest wall or mediastinal structures or metastases to thoracic lymph nodes |
| III | Tumor penetrating the diaphragm to involve the peritoneum or metastases to extrathoracic lymph nodes |
| IV | Distant blood-borne metastases |
Table 20-3 Brigham and Women’s Hospital Staging System for Malignant Pleural Mesothelioma
| Stage | Description |
|---|---|
| I | Can be extirpated surgically; no involvement of regional lymph nodes by tumor |
| II | Can be removed surgically but regional lymph nodes are involved by tumor |
| III | Inoperable; tumor involves chest wall, pericardium, or diaphragm/peritoneumRegional lymph nodes may or may not contain metastases |
| IV | Inoperable; distant (extrathoracic) metastases are present |
Some of the other clinicopathologic factors affecting prognosis have been mentioned earlier in this discussion. In multivariate statistical analyses, those that have been associated with longer survivals include an epithelial histologic subtype, stage I disease, a good clinical performance (Karnofsky) score, female gender, patient age of younger than 65 years at diagnosis, tumor-related symptoms for longer than 6 months before diagnosis, weight loss of less than 5%, negative tissue margins in surgically resected cases, serum levels of lactate dehydrogenase less than 500 IU/L, and the absence of chest pain.66,423–426 Conversely, asbestos causation, cigarette smoking, and thrombocytosis have not held up as independent negative prognosticators.423
Selected analyses have also examined the prognostic influence of cell cycle–related proteins in the tumor cells: p27 (kip1) is a cell cycle inhibitor that is down-regulated in rapidly replicating tissues; accordingly, it is not surprising that several studies have concluded that its level correlates directly with prognosis in cases of MM.427–429 The same appears to be true of p16 protein.430 On the other hand, the Ki-67 protein, an S-phase-related nuclear moiety, is preferentially expressed in actively dividing cells. Thus, one would expect that high Ki-67 indices (>30%) would be seen in aggressive MMs, and based on the results of pertinent publications,429,431 that supposition appears to be valid.
Other molecules that influence cellular adhesion, invasiveness, and motility have been assessed as possible prognostic factors for mesothelioma. Immunoreactivity for neurotensin and osteopontin have both been associated with a short survival time,432,433 whereas expression of serine protease HtrA1 and PTEN protein has been associated with longer survival.434,435
Growth factor receptors have become important targets of therapeutic interest because biologic agents that block their activity are being developed increasingly. Strong immunoexpression of epidermal growth factor receptor has been associated with improved survival in patients with mesothelioma,436 whereas high levels of platelet-derived growth factor receptor in the tumor cells has conferred a worse prognosis.
1 Millard M. Lung, pleura, and mediastinum. In: Anderson W.A.D., editor. Pathology. 6th ed. St. Louis: Mosby; 1971:875-997.
2 Klemperer P., Rabin C.B. Primary neoplasms of the pleura. Arch Pathol. 1931;11:385-401.
3 DeLajarte M., deLaJarte A.Y. Mesothelioma on the coast of Brittany, France. Ann N Y Acad Sci. 1979;330:323-332.
4 Legha S.S., Muggia F.M. Pleural mesotheliomas: clinical features and therapeutic implications. Ann Intern Med. 1977;87:613-620.
5 Elmes P.C., Simpson M.J.C. The clinical aspects of mesothelioma. Q J Med. 1976;45:427-441.
6 Aziz T., Jilaihawi A., Prakash D. The management of malignant pleural mesothelioma: single center experience in 10 years. Eur J Cardiothorac Surg. 2002;22:298-305.
7 Grundy G.W., Miller R.W. Malignant mesothelioma in childhood. Cancer. 1972;30:1216-1218.
8 Coffin C.M., Dehner L.P. Mesothelial and related neoplasms in children and adolescents: a clinicopathologic and immunohistochemical analysis of eight cases. Pediatr Pathol. 1992;12:333-347.
9 Fraire A.E., Cooper S., Greenberg S.D., et al. Mesothelioma of childhood. Cancer. 1988;62:838-847.
10 Ascoli V., Scalzo C.C., Bruno C., et al. Familial pleural malignant mesothelioma: clustering in three sisters and one cousin. Cancer Lett. 1998;130:203-207.
11 Dawson A., Gibbs A., Browne K., et al. Familial mesothelioma: details of 17 cases with histopathologic findings and mineral analysis. Cancer. 1992;70:1183-1187.
12 Krousel T., Garcas N., Rothschild H. Familial clustering of mesothelioma: a report on three affected persons in one family. Am J Prev Med. 1986;2:186-188.
13 Lynch H.T., Katz D., Markvicka S.E. Familial mesothelioma: review and family study. Cancer Genet Cytogenet. 1985;15:25-35.
14 Law M.R., Hodson M.E., Turner-Warwick M. Malignant mesothelioma of the pleura: clinical aspects and symptomatic treatment. Eur J Respir Dis. 1984;65:162-168.
15 Bonomo L., Feragalli B., Sacco R., et al. Malignant pleural disease. Eur J Radiol. 2000;34:98-118.
16 Bueno R. Mesothelioma—clinical presentation. Chest. 1999;116(suppl 6):444S-445S.
17 Neumeister W., Gillisseu A., Rasche K., et al. Pleural mesothelioma. I. Historical, epidemiological, and clinical aspects (symptoms and diagnosis). Med Klin. 2001;96:722-729.
18 Pisani R.J., Colby T.V., Williams D.E. Malignant mesothelioma of the pleura. Mayo Clin Proc. 1988;63:1234-1244.
19 Ruffie P.A. Pleural mesothelioma. Curr Opin Oncol. 1991;3:328-334.
20 Dutt P.L., Baxter J.W., O’Malley F.P., et al. Distant cutaneous metastasis of pleural mesothelioma. J Cutan Pathol. 1992;19:490-495.
21 Sussman J., Rosai J. Lymph node metastasis as the initial manifestation of malignant mesothelioma: report of six cases. Am J Surg Pathol. 1990;14:819-828.
22 Achatzy R., Beba W., Ritschler R., et al. The diagnosis, therapy, and prognosis of diffuse malignant mesothelioma. Eur J Cardiothorac Surg. 1989;3:445-448.
23 Mischler N.E., Chuprevich T., Johnson R.O., et al. Malignant mesothelioma presenting in the pleura and peritoneum. J Surg Oncol. 1979;11:185-191.
24 Metintas M., Icgun I., Elbek O., et al. Computed tomographic features in malignant pleural mesothelioma and other commonly seen pleural diseases. Eur J Radiol. 2002;41:1-9.
25 Marom E.M., Erasmus J.J., Pass H.I., et al. The role of imaging in malignant pleural mesothelioma. Semin Oncol. 2002;29:26-35.
26 Eibel K., Tuengerthal S., Schoenberg S.O. The role of new imaging techniques in diagnosis and staging of malignant pleural mesothelioma. Curr Opin Oncol. 2003;15:131-138.
27 Knuuttila A., Kivisaari L., Kivisaari A., et al. Evaluation of pleural disease using MR and CT, with special reference to malignant pleural mesothelioma. Acta Radiol. 2001;42:502-507.
28 Hammar S.P. The pathology of benign and malignant pleural disease. Chest Surg Clin N Am. 1994;4:405-430.
29 Hillerdal G. The human evidence: parenchymal and pleural changes. Ann Occup Hyg. 1994;38:561-567.
30 Chahinian A.P., Pajak T.F., Holland J.F., et al. Diffuse malignant mesothelioma: prospective evaluation of 69 patients. Ann Intern Med. 1982;96:746-755.
31 DePangher-Manzini V., Brollo A., Bianchi C. Thrombocytosis in malignant pleural mesothelioma. Tumori. 1990;76:576-578.
32 Nakano T., Fujii J., Tamura S., et al. Thrombocytosis in patients with malignant pleural mesothelioma. Cancer. 1986;58:1699-1701.
33 Nakano T., Chahinian A.P., Shinjo M., et al. Interleukin-6 and its relationship to clinical parameters in patients with malignant pleural mesothelioma. Br J Cancer. 1998;77:907-912.
34 Shah I., Salvatore J.R., Kummet T., et al. Pseudomesotheliomatous carcinoma involving pleura and peritoneum: a clinicopathologic and immunohistochemical study of three cases. Ann Diagn Pathol. 1999;3:148-159.
35 Koss M.N., Fleming M., Przygodski R.M., et al. Adenocarcinoma simulating mesothelioma: a clinicopathologic and immunohistochemical study of 29 cases. Ann Diagn Pathol. 1998;2:93-102.
36 Hartmann C.A., Schutze H. Mesothelioma-like tumors of the pleura: a review of 72 autopsy cases. Cancer Res Clin Oncol. 1994;120:331-347.
37 Kobashi Y., Matsushima T., Irei T. Clinicopathological analysis of lung cancer resembling malignant pleural mesothelioma. Respirology. 2005;10(5):660-665.
38 Maeda R., Isowa N., Kawasaki Y., et al. Pseudomesotheliomatous carcinoma of the lung. Jpn J Thorac Surg. 2007;60:555-558.
39 Jaklitsch M.T., Grondin S.C., Sugarbaker D.J. Treatment of malignant mesothelioma. World J Surg. 2001;25:210-217.
40 Grossebner M.W., Arifi A.A., Goddard M., et al. Mesothelioma—VATS biopsy and lung mobilization improves diagnosis and palliation. Eur J Cardiothorac Surg. 1999;16:619-623.
41 Attanoos R.L., Gibbs A.R. The comparative accuracy of different pleural biopsy techniques in the diagnosis of malignant mesothelioma. Histopathology. 2008;53:340-344.
42 Roberts G.H., Campbell G.H. Exfoliative cytology of diffuse mesothelioma. J Clin Pathol. 1972;25:557-582.
43 Nguyen G.K., Akin M.R., Villanueva R.R., et al. Cytopathology of malignant mesothelioma of the pleura in fine needle aspiration biopsies. Diagn Cytopathol. 1999;21:253-259.
44 Antman K.H. Clinical presentation and natural history of benign and malignant mesothelioma. Semin Oncol. 1981;8:313-320.
45 Lee Y.C., Light R.W., Musk A.W. Management of malignant pleural mesothelioma: a critical review. Curr Opin Pulm Med. 2000;6:267-274.
46 Butchart E.G. Contemporary management of malignant pleural mesothelioma. Oncologist. 1999;4:488-500.
47 Zellos L.S., Sugarbaker D.J. Diffuse malignant mesothelioma of the pleural space and its management. Oncology. 2002;16:916-925.
48 Kindler H.L. Malignant pleural mesothelioma. Curr Treat Options Oncol. 2000;1:313-326.
49 Senan S. Indications and limitations of radiotherapy in malignant pleural mesothelioma. Curr Opin Oncol. 2003;15:144-147.
50 Grondin S.C., Sugarbaker D.J. Pleuropneumonectomy in the treatment of malignant pleural mesothelioma. Chest. 1999;116(suppl 6):450S-454S.
51 Kaiser L.R. New therapies in the treatment of malignant pleural mesothelioma. Semin Thorac Cardiovasc Surg. 1997;9:383-390.
52 Erkilic S., Sari I., Tuncozgur B. Localized pleural malignant mesothelioma. Pathol Int. 2001;51:812-815.
53 Okamura H., Kamai T., Mitsuno A., et al. Localized malignant mesothelioma of the pleura. Pathol Int. 2001;51:654-660.
54 Crotty T.B., Myers J.L., Katzenstein A.L., et al. Localized malignant mesothelioma: a clinicopathologic and flow cytometric study. Am J Surg Pathol. 1994;18:357-363.
55 Christoffel T., Teret S.P. Epidemiology and the law: courts and confidence intervals. Am J Public Health. 1991;81:1661-1666.
56 Wagner J.C., Sleggs C.A., Marchand P. Diffuse pleural mesothelioma and asbestos exposure in North-Western Cape Province. Br J Ind Med. 1960;17:260-271.
57 Smither W.J. Asbestos, asbestosis, and mesothelioma of the pleura. Proc R Soc Med. 1966;59:57-59.
58 Hill I.D., Doll R., Knox J.F. Mortality among asbestos workers. Proc R Soc Med. 1966;59:59-60.
59 Mann R.H., Grosh J.L., O’Donnell W.M. Mesothelioma associated with asbestosis: a report of 3 cases. Cancer. 1966;19:521-526.
60 Butnor K.J., Sporn T.A., Roggli V.L. Exposure to brake dust and malignant mesothelioma: a study of 10 cases with mineral fiber analyses. Ann Occup Hyg. 2003;47:325-330.
61 Valic F. The asbestos dilemma. I. Assessment of risk. Arh Hig Rada Toksikol. 2002;53:153-167.
62 Roggli V.L., Sharma A., Butnor K.J., et al. Malignant mesothelioma and occupational exposure to asbestos: a clinicopathological correlation of 1445 cases. Ultrastruct Pathol. 2002;26:55-65.
63 McDonald J.C., Armstrong B.G., Edwards C.W., et al. Case-referent study of young adults with mesothelioma. I. Lung fiber analyses. Ann Occup Hyg. 2001;45:513-518.
64 Britton M. The epidemiology of mesothelioma. Semin Oncol. 2002;29:18-25.
65 Marchevsky A.M., Wick M.R. Current controversies regarding the role of asbestos exposure in the causation of malignant mesothelioma: the need for an evidence-based approach to develop medicolegal guidelines. Ann Diagn Pathol. 2003;7:321-332.
66 Klebe S., Brownlee N.A., Mahar A., et al. Sarcomatoid mesothelioma: a clinical-pathologic correlation of 326 cases. Mod Pathol. 2010;23:470-479.
67 Bianchi C., Bianchi T., Ramani L. Malignant mesothelioma of the pleura among women. Med Lav. 2004;95:376-380.
68 Roggli V.L., Pratt P.C., Brody A.R. Asbestos content of lung tissue in asbestos-associated diseases: a study of 110 cases. Br J Ind Med. 1986;43:18-28.
69 Roggli V.L., Pratt P.C., Brody A.R. Analysis of tissue mineral fiber content. In: Roggli V.L., Greenberg S.D., Pratt P.C., editors. Pathology of Asbestos-Associated Diseases. Boston: Little Brown; 1992:299-345.
70 Ilgren E.B., Wagner J.C. Background incidence of mesothelioma: animal and human evidence. Regul Toxicol Pharmacol. 1991;13:133-149.
71 Peterson J.T.Jr, Greenberg S.D., Buffler P.A. Non-asbestos-related malignant mesothelioma: a review. Cancer. 1984;54:951-960.
72 Craighead J.E., Mossman B.T. Pathogenesis of mesothelioma. In: Antman K.H., Aisner J., editors. Asbestos-related Malignancy. New York: Grune & Stratton; 1987:151-162.
73 Lanphear B.P., Buncher C.R. Latent period for malignant mesothelioma of occupational origin. J Occup Med. 1992;34:718-721.
74 Pass H.I., Mew D.J. In-vitro and in-vivo studies of mesothelioma. J Cell Biochem. 1996;24(suppl):142-151.
75 Manning C.B., Vallyathan V., Mossman B.T. Diseases caused by asbestos: mechanisms of injury and disease development. Int Immunopharmacol. 2002;2:191-200.
76 Fitzpatrick D.R., Peroni D.J., Bielefeldt-Ohmann H. The role of growth factors and cytokines in the tumorigenesis and immunobiology of malignant mesothelioma. Am J Resp Cell Mol Biol. 1995;12:455-460.
77 Attanoos R.L., Thomas D.H., Gibbs A.R. Synchronous diffuse malignant mesothelioma and carcinomas in asbestos-exposed individuals. Histopathology. 2003;43:387-392.
78 Huncharek M. Non-asbestos-related diffuse malignant mesothelioma. Tumori. 2002;88:1-9.
79 Weiner S.J., Neragi-Miandoab S. Pathogenesis of malignant pleural mesothelioma and the role of environmental and genetic factors. J Cancer Res Clin Oncol. 2009;135:15-27.
80 Falchero L., Coiffier B., Guibert B., et al. Malignant mesothelioma of the pleura following radiotherapy of Hodgkin’s disease. Bull Cancer. 1996;83:964-968.
81 Mizuki M., Yukishige K., Abe Y., et al. A case of malignant pleural mesothelioma following exposure to atomic radiation in Nagasaki. Respirology. 1997;2:201-205.
82 Antman K.H., Ruxer R.L.Jr, Aisner J., et al. Mesothelioma following Wilms’ tumor in childhood. Cancer. 1984;54:367-369.
83 Neugut A.I., Ahsen H., Antman K.H. Incidence of malignant pleural mesothelioma after thoracic radiotherapy. Cancer. 1997;80:948-950.
84 Weissmann L.B., Corson J.M., Neugut A.I., et al. Malignant mesothelioma following treatment for Hodgkin’s disease. J Clin Oncol. 1996;14:2098-2100.
85 Cavazza A., Travis L.B., Travis W.D., et al. Post-irradiation malignant mesothelioma. Cancer. 1996;77:1379-1385.
86 Hillerdal G., Berg J. Malignant mesothelioma secondary to chronic inflammation and old scars. Cancer. 1985;55:1968-1972.
87 Vertun-Baranowska B., Szymanska D., Szturmowicz M. Malignant mesothelioma. I. Evaluation of autopsy specimens. Pneumonol Pol. 1988;56:47-54.
88 Livneh A., Langevitz P., Pras M. Pulmonary associations in familial Mediterranean fever. Curr Opin Pulm Med. 1999;5:326-331.
89 Lidar M., Pras M., Langevitz P., et al. Thoracic and lung involvement in familial Mediterranean fever. Clin Chest Med. 2002;23:505-511.
90 Huncharek M., Kelsey K., Muscat J., et al. Parental cancer and genetic predisposition in malignant pleural mesothelioma: a case-control study. Cancer Lett. 1996;102:205-208.
91 Van Kaick G., Dalheimer A., Hornick S., et al. The German Thorotrast Study: recent results and assessment of risks. Radiat Res. 1999;152(suppl 6):S64-S71.
92 Andersson M., Wallin H., Jonsson M., et al. Lung carcinoma and malignant mesothelioma in patients exposed to Thorotrast: incidence, histology, and p53 status. Int J Cancer. 1995;63:330-336.
93 Emri S., Demir A., Dogan M., et al. Lung diseases due to environmental exposures to erionite and asbestos in Turkey. Toxicol Lett. 2002;127:251-257.
94 Dumortier P., Gocmen A., Laurent K., et al. The role of environmental and occupational exposures in Turkish immigrants with fiber-related disease. Eur Respir J. 2001;17:922-927.
95 Strickler H.D., Goedert J.J., Fleming M., et al. Simian virus 40 and pleural mesothelioma in humans. Cancer Epidemiol Biomarkers Prev. 1996;5:473-475.
96 Dopp E., Poser I., Papp T. Interphase FISH analysis of cell cycle genes in asbestos-treated human mesothelial cells (HMC), SV40-transformed HMB, and mesothelioma cells. Cell Mol Biol. 2002;48:OL271-OL277. (online publication)
97 Mutti L., Carbone M., Giordano G.G., et al. Simian virus-40 and human cancer. Monaldi Arch Chest Dis. 1998;53:198-201.
98 Simsir A., Fetsch P., Bedrossian C.W., et al. Absence of SV-40 large-T antigen (Tag) in malignant mesothelioma effusions: an immunocytochemical study. Diagn Cytopathol. 2001;25:203-207.
99 Foddis R., DeRienzo A., Broccoli D., et al. SV40 infection induces telomerase activity in human mesothelial cells. Oncogene. 2002;21:1434-1442.
100 Shah K.V. SV40 and human cancer: a review of recent data. Int J Cancer. 2007;120:215-223.
101 Hashimoto N., Oda T., Kadota K. An ultrastructural study of malignant mesotheliomas in two cows. Jpn J Vet Sci. 1989;51:327-336.
102 Colbourne C.M., Bolton J.R., Mills J.N., et al. Mesothelioma in horses. Aust Vet J. 1992;69:275-278.
103 Misdorp W. Tumors in calves: comparative aspects. J Comp Pathol. 2002;127:96-105.
104 Cunningham A.A., Dhillon A.P. Pleural malignant mesothelioma in a captive clouded leopard (Neofelis nebulosa nebulosa). Vet Rec. 1998;143:22-24.
105 Baskerville A. Mesothelioma in the calf. Pathol Vet. 1967;4:149-156.
106 Shibuya K., Tajima M., Yamate J. Histological classification of 62 spontaneous mesotheliomas in F344 rats. Jpn J Vet Sci. 1990;52:1313-1317.
107 Rostami M., Tateyama S., Uchida K., et al. Tumors in domestic animals examined during a ten-year period (1980–1989) at Miyazaki University. J Vet Med Sci. 1994;56:403-405.
108 Rusch V.W., Godwin J.D., Shuman W.P. The role of computed tomography scanning in the initial assessment and the followup of malignant pleural mesothelioma. J Thorac Cardiovasc Surg. 1988;96:171-177.
109 Golla B., Singh S.P., Pinkard N.B., et al. Rapidly fatal bilateral malignant mesothelioma. Semin Roentgenol. 1998;33:306-308.
110 Nakatsuka S., Yao M., Hoshida Y., et al. Pyothorax-associated lymphoma: a review of 106 cases. J Clin Oncol. 2002;20:4255-4260.
111 Falconieri G., Bussani R., Mirra M., et al. Pseudomesotheliomatous angiosarcoma: a pleuropulmonary lesion simulating pleural mesothelioma. Histopathology. 1997;30:419-424.
112 Allen T.C., Cagle P.T., Churg A.M., et al. Localized malignant mesothelioma. Am J Surg Pathol. 2005;29:866-873.
113 Wick M.R. Pleural cytology, tumor markers, and immunohistochemistry. In: Light R.W., Lee Y.C.G., editors. Textbook of Pleural Diseases. London: Arnold Publishers; 2003:256-281.
114 DiBonito L., Falconieri G., Colautti I., et al. Cytopathology of malignant mesothelioma: a study of its patterns and histological bases. Diagn Cytopathol. 1993;9:25-31.
115 Sherman M.E., Mark E.J. Effusion cytology in the diagnosis of malignant epithelioid and biphasic pleural mesothelioma. Arch Pathol Lab Med. 1990;114:845-851.
116 Johnston W.W. The malignant pleural effusion: a review of cytopathologic diagnoses of 584 specimens from 472 consecutive patients. Cancer. 1985;56:905-909.
117 Matzel W. Biochemical and cytological features of diffuse mesothelioma of the pleura. Arch Geschwulstforsch. 1985;55:259-264.
118 Castelain G., Castelain C., Pretet S., et al. Cytodiagnosis of pleural mesotheliomas. Presse Med. 1969;77:197-199.
119 Castelain G., Ioannou J., Castelain C., et al. Cytodiagnosis in lung diseases: its importance and its value. A study of 945 cases. Presse Med. 1968;76:2219-2221.
120 Yokoi T., Mark E.J. Atypical mesothelial hyperplasia associated with bronchogenic carcinoma. Hum Pathol. 1991;22:695-699.
121 Cavazza A., Rossi G., Agostini L., et al. Small-cell mesothelioma of the pleura: description of a case. Pathologica. 2002;94:247-252.
122 Hammar S.P., Bolen J.W. Sarcomatoid pleural mesothelioma. Ultrastruct Pathol. 1985;9:337-343.
123 Colby T.V. Malignancies in the lung and pleura mimicking benign processes. Semin Diagn Pathol. 1995;12:30-44.
124 Khalidi H.S., Medeiros L.J., Battifora H. Lymphohistiocytoid mesothelioma: an often-misdiagnosed variant of sarcomatoid malignant mesothelioma. Am J Clin Pathol. 2000;113:649-654.
125 Galateau-Sallé F., Attanoos R., Gibbs A.R., et al. Lymphohistiocytoid variant of malignant mesothelioma of the pleura: a series of 22 cases. Am J Surg Pathol. 2007;31:711-716.
126 Cibas E.S., Corson J.M., Pinkus G.S. The distinction of adenocarcinoma from malignant mesothelioma in cell blocks of effusions. Hum Pathol. 1987;18:67-74.
127 Renshaw A.A., Dean B.R., Antman K.H., et al. The role of cytologic evaluation of pleural fluid in the diagnosis of malignant mesothelioma. Chest. 1997;111:106-109.
128 Kimura N., Dota K., Araya Y., et al. Scoring system for differential diagnosis of malignant mesothelioma and reactive mesothelial cells on cytology specimens. Diagn Cytopathol. 2009;37:885-890.
129 Nind A.R., Attanoos R.L., Gibbs A.R. Unusual intraparenchymal growth patterns of malignant pleural mesothelioma. Histopathology. 2003;42:150-155.
130 Attanoos R.L., Gibbs A.R. The pathology associated with therapeutic procedures in malignant mesothelioma. Histopathology. 2004;45:393-397.
131 Corson J.M. Pathology of diffuse malignant pleural mesothelioma. Semin Thorac Cardiovasc Surg. 1997;9:347-355.
132 Mogi A., Nabeshima K., Hamasaki M., et al. Pleural malignant mesothelioma with invasive micropapillary component and its association with pulmonary metastasis. Pathol Int. 2009;59:874-879.
133 Donaldson J.C., Elliott R.C., Kaminsky D.B., et al. Psammoma bodies in pleural fluid associated with a mesothelioma: case report. Mil Med. 1979;144:476-479.
134 Suzuki Y. Diagnostic criteria for human diffuse malignant mesothelioma. Acta Pathol Jpn. 1992;42:767-786.
135 Shia J., Erlandson R.A., Klimstra D.S. Deciduoid mesothelioma: a report of 5 cases and literature review. Ultrastruct Pathol. 2002;26:355-363.
136 Monaghan H., Al-Nafussi A. Deciduoid pleural mesothelioma. Histopathology. 2001;39:104-106.
137 Ordóñez N.G. Epithelial mesothelioma with deciduoid features: report of four cases. Am J Surg Pathol. 2000;24:816-823.
138 Ordóñez N.G., Mackay B. Glycogen-rich mesothelioma. Ultrastruct Pathol. 1999;23:401-406.
139 Dessy E., Falleni M., Braidotti P., et al. Unusual clear-cell variant of epithelioid mesothelioma. Arch Pathol Lab Med. 2001;125:1588-1590.
140 Ordóñez N.G., Myhre M., Mackay B. Clear cell mesothelioma. Ultrastruct Pathol. 1996;20:331-336.
141 Umezu H., Kuwata K., Ebe Y., et al. Microcystic variant of localized malignant mesothelioma accompanying an adenomatoid tumor-like lesion. Pathol Int. 2002;52:416-422.
142 Mukonoweshuro P., Attanoos R.L., Smith M.E. Nodular glomeruloid pleuroblastoma: a biphasic pleural-based malignant tumor with immature elements. Virchows Arch. 2006;449:253-257.
143 Henderson D.W., Shilkin K.B., Whitaker D. Reactive mesothelial hyperplasia versus mesothelioma, including mesothelioma in-situ: a brief review. Am J Clin Pathol. 1998;110:397-404.
144 Whitaker D., Henderson D.W., Shilkin K.B. The concept of mesothelioma in-situ: implications for diagnosis and histogenesis. Semin Diagn Pathol. 1992;9:151-161.
145 Bolen J.W. Tumors of serosal tissue origin. Clin Lab Med. 1987;7:31-50.
146 Carter D., Otis C.N. Three types of spindle cell tumors of the pleura: fibroma, sarcoma, and sarcomatoid mesothelioma. Am J Surg Pathol. 1988;12:747-753.
147 Avellini C., Alampi G., Cocchi V., et al. Malignant sarcomatoid mesothelioma of the pleura. Pathologica. 1991;83:335-340.
148 Andrion A., Mazzucco G., Bernardi P., et al. Sarcomatous tumor of the chest wall with osteochondroid differentiation: evidence of mesothelial origin. Am J Surg Pathol. 1989;13:707-712.
149 Okamoto T., Yokota S., Shinkawa K., et al. Pleural malignant mesothelioma with osseous, cartilaginous, and rhabdomyoblastic differentiation. J Jpn Resp Soc. 1998;36:696-701.
150 Yousem S.A., Hochholzer L. Malignant mesotheliomas with osseous and cartilaginous differentiation. Arch Pathol Lab Med. 1987;111:62-66.
151 Klebe S., Mahar A., Henderson D.W., et al. Malignant mesothelioma with heterologous elements: clinicopathological correlation of 27 cases and literature review. Mod Pathol. 2008;21:1084-1094.
152 Sterrett G.F., Whitaker D., Shilkin K.B., et al. Fine needle aspiration cytology of malignant mesothelioma. Acta Cytol. 1987;31:185-193.
153 Colby T.V. The diagnosis of desmoplastic malignant mesothelioma. Am J Clin Pathol. 1998;110:135-136.
154 Wilson G.E., Hasleton P.S., Chatterjee A.K. Desmoplastic malignant mesothelioma: a review of 17 cases. J Clin Pathol. 1992;45:295-298.
155 Cantin R., Al-Jabi M., McCaughey W.T.E. Desmoplastic diffuse mesothelioma. Am J Surg Pathol. 1982;6:215-222.
156 Cagle P.T., Churg A. Differential diagnosis of benign and malignant mesothelial proliferations on pleural biopsies. Arch Pathol Lab Med. 2005;129:1421-1427.
157 Churg A., Colby T.V., Cagle P.T., et al. The separation of benign and malignant mesothelial proliferations. Am J Surg Pathol. 2000;24:1183-2000.
158 Schramm A., Opitz I., Thies S., et al. Prognostic significance of epithelial-mesenchymal transition in malignant pleural mesothelioma. Eur J Cardiothorac Surg. 2010;37:566-572.
159 Mayall F.G., Gibbs A.R. The histology and immunohistochemistry of small cell mesothelioma. Histopathology. 1992;20:47-51.
160 Wick M.R., Ritter J.H., Dehner L.P. Malignant rhabdoid tumors: a clinicopathologic review and conceptual discussion. Semin Diagn Pathol. 1995;12:233-248.
161 Puttagunta L., Vriend R.A., Nguyen G.K. Deciduoid epithelial mesothelioma of the pleura with focal rhabdoid change. Am J Surg Pathol. 2000;24:1440-1443.
162 Ordóñez N.G. Mesothelioma with rhabdoid features: an ultrastructural and immunohistochemical study of 10 cases. Mod Pathol. 2006;19:373-383.
163 Machado I., Noguera R., Santonja N., et al. Immunohistochemical study as a tool in differential diagnosis of pediatric malignant rhabdoid tumor. Appl Immunohistochem Mol Morphol. 2010;18:150-158.
164 Tanzi S., Tiseo M., Internullo E., et al. Localized malignant pleural mesothelioma: report of two cases. J Thorac Oncol. 2009;4:1038-1040.
165 Teo A., Hemmings C., Miller R. Sarcomatoid localized mesothelioma mimicking intrapulmonary synovial sarcoma: a case report and review of the literature. Pathology. 2010;42:182-184.
166 Nakas A., Martin-Ucar A.E., Edwards J.G., et al. Localised malignant pleural mesothelioma: a separate clinical entity requiring aggressive local surgery. Eur J Cardiothorac Surg. 2008;33:303-306.
167 Kannerstein M., Churg J., Magner D. Histochemistry in the diagnosis of malignant mesothelioma. Ann Clin Lab Sci. 1973;3:207-211.
168 Cook H.C. A histochemical characterization of malignant tumor mucins as a possible aid in the identification of metastatic deposits. Med Lab Technol. 1973;30:217-224.
169 Griffiths M.H., Riddell R.J., Xipell J.M. Malignant mesothelioma: a review of 35 cases with diagnosis and prognosis. Pathology. 1980;12:591-603.
170 Kwee W.S., Veldhuizen R.W., Golding R.P., et al. Histologic distinction between malignant mesothelioma, benign pleural lesions, and carcinoma metastasis. Virchows Arch Pathol Anat. 1982;397:287-299.
171 Bertoldo E., Bernardi P., Gugliotta P. Histochemical and immunohistochemical methods in the diagnosis of mesothelioma. Pathologica. 1987;79:447-455.
172 Lucas J.G., Tuttle S.E. Diagnostic histochemical and immunohistochemical studies in malignant mesothelioma. J Surg Oncol. 1987;35:30-34.
173 McCaughey W.T.E., Colby T.V., Battifora H., et al. Diagnosis of diffuse malignant mesothelioma: experience of a US/Canadian Mesothelioma Panel. Mod Pathol. 1991;4:342-353.
174 Wick M.R., Loy T., Mills S.E., et al. Malignant epithelioid pleural mesothelioma versus peripheral pulmonary adenocarcinoma: a histochemical, ultrastructural, and immunohistologic study of 103 cases. Hum Pathol. 1990;21:759-766.
175 Arai H., Endo M., Sasai Y., et al. Histochemical demonstration of hyaluronic acid in a case of pleural mesothelioma. Am Rev Respir Dis. 1975;111:699-702.
176 Hammar S.P., Bockus D.E., Remington F.L., et al. Mucin-positive epithelial mesotheliomas: a histochemical, immunohistochemical, and ultrastructural comparison with mucin-producing pulmonary adenocarcinomas. Ultrastruct Pathol. 1996;20:293-325.
177 McMeekin W., Kennedy A., McNicol A.M. Combined immunocytochemical and nucleolar organizer region staining: some technical aspects. Med Lab Sci. 1989;46:11-15.
178 Smith P.J., Skilbeck N.Q., Harrison A., et al. The effect of a series of fixatives on the AgNOR technique. J Pathol. 1988;155:109-112.
179 Leong A.S.Y., Raymond W.A. Demonstration of AgNOR-related proteins in microwave-fixed tissues. J Pathol. 1988;156:352.
180 Aris J.P., Blobel G. cDNA cloning and sequencing of human fibrillarin, a conserved nucleolar protein recognized by autoimmune antisera. Proc Natl Acad Sci U S A. 1991;88:931-935.
181 Ayres J.G., Crocker J.G., Skilbeck N.Q. Differentiation of malignant from normal and reactive mesothelial cells by the argyrophil technique for nucleolar organizer region-asssociated proteins. Thorax. 1988;43:366-370.
182 Bethwaite P.B., Delahunt B., Holloway L.J., et al. Comparison of silver-staining nucleolar organizer region (AgNOR) counts and proliferating cell nuclear antigen (PCNA) expression in reactive mesothelial hyperplasia and malignant mesothelioma. Pathology. 1995;27:1-4.
183 Ramesh K., Gahukamble L., Al-Fituri O. Utility of AgNOR technique in distinguishing reactive mesothelial hyperplasia, malignant mesothelioma, and pulmonary adenocarcinoma. Cent Afr J Med. 1994;40:265.
184 Wolanski K.D., Whitaker D., Shilkin K.B., et al. The use of epithelial membrane antigen and silver-stained nucleolar organizer region testing in the differential diagnosis of mesothelioma from benign reactive mesothelioses. Cancer. 1998;82:583-590.
185 Pomjanski N., Motherby H., Buckstegge B., et al. Early diagnosis of mesothelioma in serous effusions using AgNOR analysis. Anal Quant Cytol Histol. 2001;23:151-160.
186 Onofre F.B., Onofre A.S., Pomjanski N., et al. 9p21 deletion in the diagnosis of malignant mesothelioma in serous effusions additional to immunocytochemistry, DNA-ICM, and AgNOR analysis. Cancer. 2008;114:204-215.
187 Wang N.S. Electron microscopy in the diagnosis of pleural mesotheliomas. Cancer. 1973;31:1046-1054.
188 McDonald A.D., Magner D., Eyssen G. Primary malignant mesothelial tumors in Canada, 1960–1968: a pathologic review by the Mesothelioma Panel of the Canadian Tumor Reference Center. Cancer. 1973;31:869-876.
189 David J.M. Ultrastructure of human mesotheliomas. J Natl Cancer Inst USA. 1974;52:1715-1725.
190 Warhol M.J., Hickey W.F., Corson J.M. Malignant mesothelioma: ultrastructural distinction from adenocarcinoma. Am J Surg Pathol. 1982;6:307-314.
191 Kobzik L., Antman K.H., Warhol M.J. The distinction of mesothelioma from adenocarcinoma in malignant effusions by electron microscopy. Acta Cytol. 1985;29:219-225.
192 Suzuki Y., Kannerstein M. Ultrastructure of human malignant diffuse mesothelioma. Am J Pathol. 1976;85:241-262.
193 Stoebner P., Brambilla E. Ultrastructure of pleural tumors. Pathol Res Pract. 1982;173:402-416.
194 Leong A.S.Y., Stevens M.W., Mukherjee T.M. Malignant mesothelioma: cytologic diagnosis with histologic, immunohistochemical, and ultrastructural correlation. Semin Diagn Pathol. 1992;9:141-150.
195 Dardick I., Jabi M., McCaughey W.T.E., et al. Diffuse epithelial mesothelioma: a review of the ultrastructural spectrum. Ultrastruct Pathol. 1987;11:503-533.
196 Oury T.D., Hammar S.P., Roggli V.L. Ultrastructural features of diffuse malignant mesotheliomas. Hum Pathol. 1998;29:1382-1392.
197 Ferenczy A. Diagnostic electron microscopy in gynecologic pathology. Pathol Annu. 1979;14(part I):353-381.
198 Chen H.P., Berardi R.S. A light and electron microscopic study of lung cancers: clinical implications. Int Surg. 1993;78:124-126.
199 McGregor D.H., Dixon A.Y., McGregor D.K. Adenocarcinoma of the lung: a comparative diagnostic study using light and electron microscopy. Hum Pathol. 1988;19:910-913.
200 Klima M., Bossart M.I. Sarcomatous type of malignant mesothelioma. Ultrastruct Pathol. 1983;4:349-358.
201 Dardick I., Srigley J.R., McCaughey W.T.E., et al. Ultrastructural aspects of the histogenesis of diffuse and localized mesothelioma. Virchows Arch Pathol Anat. 1984;402:373-388.
202 Aerts J.G., Delahaye M., van der Kwast T.H., et al. The high post-test probability of a cytological examination renders further investigations to establish a diagnosis of epithelial malignant pleural mesothelioma redundant. Diagn Cytopathol. 2006;34:523-527.
203 Chirieac L.R., Corson J.M. Pathologic evaluation of malignant pleural mesothelioma. Semin Thorac Cardiovasc Surg. 2009;21:121-124.
204 Hammar S.P. Macroscopic, histologic, histochemical, immunohistochemical, and ultrastructural features of mesothelioma. Ultrastruct Pathol. 2006;30:3-17.
205 Leong A.S.Y., Wick M.R., Swanson P.E. Immunohistology and Electron Microscopy of Anaplastic and Pleomorphic Tumors. Cambridge, England, United Kingdom: Cambridge University Press, 1997.
206 Corson J.M., Pinkus G.S. Mesothelioma: profile of keratin proteins and carcinoembryonic antigen. Am J Pathol. 1982;108:80-87.
207 Bejui-Thivolet F., Patricot L.M., Vauzelle J.L. Keratins in malignant mesothelioma and pleural adenocarcinomas. Pathol Res Pract. 1984;179:67-73.
208 Churg A. Immunohistochemical staining for vimentin and keratin in malignant mesothelioma. Am J Surg Pathol. 1985;9:360-365.
209 Moll R., Dhouailly D., Sun T.T. Expression of keratin 5 as a diagnostic feature of epithelial and biphasic mesotheliomas. Virchows Arch B. 1989;58:129-145.
210 Kahn H.J., Thorner P.S., Yeger H., et al. Distinct keratin patterns demonstrated by immunoperoxidase staining of adenocarcinoma, carcinoids, and mesotheliomas using polyclonal and monoclonal antikeratin antibodies. Am J Clin Pathol. 1986;86:566-574.
211 Ordóñez N.G. Value of cytokeratin 5/6 immunostaining in distinguishing epithelial mesothelioma of the pleura from lung adenocarcinoma. Am J Surg Pathol. 1998;22:1215-1221.
212 Cury P.M., Butcher D.N., Fisher C., et al. Value of the mesothelium-associated antibodies thrombomodulin, cytokeratin 5/6, calretinin, and CD44H in distinguishing epithelioid pleural mesothelioma from adenocarcinoma metastatic to the pleura. Mod Pathol. 2000;13:107-112.
213 Blobel G.A., Moll R., Franke W.W., et al. The intermediate filament cytoskeleton of malignant mesothelioma and its diagnostic significance. Am J Pathol. 1985;121:235-247.
214 Wick M.R. Immunohistochemical approaches to the diagnosis of undifferentiated malignant tumors. Ann Diagn Pathol. 2008;12:72-84.
215 Van Der Kwast T.H., Versnel M.A., Delahaye M., et al. Expression of epithelial membrane antigen on malignant mesothelioma cells: an immunocytochemical and immunoelectron microscopic study. Acta Cytol. 1988;32:169-174.
216 Kawai T., Greenberg S.D., Truong L.D., et al. Differences in lectin binding of malignant pleural mesothelioma and adenocarcinoma of the lung. Am J Pathol. 1988;130:401-410.
217 Pfaltz M., Odermatt B., Christen B., et al. Immunohistochemistry in the diagnosis of malignant mesothelioma. Virchows Arch Pathol Anat. 1987;411:387-393.
218 Leong A.S.Y., Parkinson R., Milios J. Thick cell membranes revealed by immunocytochemical staining: a clue to the diagnosis of mesothelioma. Diagn Cytopathol. 1990;6:9-13.
219 Dejmek A., Hjerpe A. Reactivity of six antibodies in effusions of mesothelioma, adenocarcinoma, and mesotheliosis: stepwise logistic regression analysis. Cytopathology. 2000;11:8-17.
220 Salman W.D., Eyden B., Shelton D., et al. An EMA-negative, desmin-positive malignant mesothelioma: limitations of immunohistochemistry? J Clin Pathol. 2009;63:651-662.
221 Villena V., Lopez-Encuentra A., Echave-Sustaeta J., et al. Diagnostic value of CA-549 in pleural fluid: comparison with CEA, CA15-3, and CA72-4. Lung Cancer. 2003;40:289-294.
222 Comin C.E., Novelli L., Boddi V., et al. Calretinin, thrombomodulin, CEA, and CD15: a useful combination of immunohistochemical markers for differentiating pleural epithelioid mesothelioma from peripheral pulmonary adenocarcinoma. Hum Pathol. 2001;32:529-536.
223 Carella R., Deleonardi G., D’Errico A., et al. Immunohistochemical panels for differentiating epithelial malignant mesothelioma from lung adenocarcinoma: a study with logistic regression analysis. Am J Surg Pathol. 2001;25:43-50.
224 Lau S.K., Luthringer D.J., Eisen R.N. Thyroid transcription factor-1: a review. Appl Immunohistochem Molec Morphol. 2002;10:97-102.
225 Hecht J.L., Pinkus J.L., Weinstein L.J., et al. The value of thyroid transcription factor-1 in cytologic preparations as a marker for metastatic adenocarcinoma of lung origin. Am J Clin Pathol. 2001;116:483-488.
226 Yatabe Y., Mitsudomi T., Takahashi T. Thyroid transcription factor-1 expression in pulmonary adenocarcinomas. Am J Surg Pathol. 2002;26:767-773.
227 Zamecnik J., Kodet R. Value of thyroid transcription factor-1 and surfactant apoprotein-A in the differential diagnosis of pulmonary carcinomas: a study of 109 cases. Virchows Arch A. 2002;440:353-361.
228 Ordóñez N.G. Value of thyroid transcription factor-1, E-cadherin, BG8, WT1, and CD44S immunostaining in distinguishing epithelial pleural mesothelioma from pulmonary and non-pulmonary adenocarcinoma. Am J Surg Pathol. 2000;24:598-606.
229 Bejarano P.A., Mousavi F. Incidence and significance of cytoplasmic thyroid transcription factor-1 immunoreactivity. Arch Pathol Lab Med. 2003;127:193-195.
230 Bishop J.A., Sharma R., Illei P.B. Napsin A and thyroid transcription factor-1 expression in carcinomas of the lung, breast, pancreas, colon, kidney, thyroid, and malignant mesothelioma. Hum Pathol. 2010;41:20-25.
231 Ordóñez N.G. The immunohistochemical diagnosis of epithelial mesothelioma. Hum Pathol. 1999;30:313-323.
232 Dejmek A., Brockstedt U., Hjerpe A. Optimization of a battery using nine immunocytochemical variables for distinguishing between epithelial mesothelioma and adenocarcinoma. APMIS. 1997;105:889-894.
233 Sheibani K., Battifora H., Burke J.S. Antigenic phenotype of malignant mesotheliomas and pulmonary adenocarcinomas: an immunohistologic analysis demonstrating the value of Leu-M1 antigen. Am J Pathol. 1986;123:212-219.
234 Roberts F., Harper C.M., Downie I., et al. Immunohistochemical analysis still has a limited role in the diagnosis of malignant mesothelioma: a study of thirteen antibodies. Am J Clin Pathol. 2001;116:253-262.
235 Shield P.W., Callan J.J., Devine P.L. Markers for metastatic adenocarcinoma in serous effusion specimens. Diagn Cytopathol. 1994;11:237-245.
236 Moch H., Oberholzer M., Dalquen P., et al. Diagnostic tools for differentiating between pleural mesothelioma and lung adenocarcinoma in paraffin embedded tissue. Part I: Immunohistochemical findings. Virchows Arch Pathol Anat. 1993;423:19-27.
237 Bedrossian C.W., Bonsib S., Moran C. Differential diagnosis between mesothelioma and adenocarcinoma: a multimodal approach based on ultrastructure and immunocytochemistry. Semin Diagn Pathol. 1992;9:124-140.
238 Thor A., Ohuchi N., Szpak C.A., et al. Distribution of oncogetal antigen tumor-associated glycoprotein-72, defined by monoclonal antibody B72.3. Cancer Res. 1986;46:3118-3124.
239 Szpak C.A., Johnston W.W., Roggli V.L., et al. The diagnostic distinction between malignant mesothelioma of the pleura and adenocarcinoma of the lung as defined by a monoclonal antibody (B72.3). Am J Pathol. 1986;122:252-260.
240 Wirth P.R., Legier J.F., Wright G.L.Jr. Immunohistochemical evaluation of seven monoclonal antibodies for differentiation of pleural mesothelioma from lung adenocarcinoma. Cancer. 1991;67:655-662.
241 Latza U., Niedobitek G., Schwarting R., et al. Ber-EP4: new monoclonal antibody which distinguishes epithelia from mesothelia. J Clin Pathol. 1990;43:213-219.
242 Sheibani K., Shin S.S., Kezirian J., et al. Ber-EP4 antibody as a discriminant in the differential diagnosis of malignant mesothelioma versus adenocarcinoma. Am J Surg Pathol. 1991;15:779-784.
243 Gaffey M.J., Mills S.E., Swanson P.E., et al. Immunoreactivity for Ber-EP4 in adenocarcinomas, adenomatoid tumors, and malignant mesotheliomas. Am J Surg Pathol. 1992;16:593-599.
244 Ordóñez N.G. The immunohistochemical diagnosis of mesothelioma: a comparative study of epithelioid mesothelioma and lung adenocarcinoma. Am J Surg Pathol. 2003;27:1031-1051.
245 Ruitenbeek T., Gouw A.S., Poppema S. Immunocytology of body cavity fluids: MOC-31, a monoclonal antibody discriminating between mesothelial and epithelial cells. Arch Pathol Lab Med. 1994;118:265-269.
246 Niemann T.H., Hughes J.H., DeYoung B.R. MOC-31 aids in the differentiation of metastatic adenocarcinoma from hepatocellular carcinoma. Cancer. 1999;87:295-298.
247 Kempner D.H., Jay M.R., Stevens R.H. Human lung tumor-associated antigens of 32,000 daltons molecular weight. J Natl Cancer Inst U S A. 1979;63:1121-1129.
248 Lau S.K., Prakash S., Geller S.A., Alsabeh R. Comparative immunohistochemical profile of hepatocellular carcinoma, cholangiocarcinoma, and metastatic adenocarcinoma. Hum Pathol. 2002;33:1175-1181.
249 Gonzalez-Lois C., Ballestin C., Sotelo M.T., et al. Combined use of novel epithelial (MOC-31) and mesothelial (HBME-1) immunohistochemical markers for optimal first-line diagnostic distinction between mesothelioma and metastatic carcinoma in pleura. Histopathology. 2001;38:528-534.
250 LePender J., Marionneau S., Cailleau-Thomas A., et al. ABH and Lewis histo-blood group antigens in cancer. APMIS. 2001;109:9-31.
251 Steplewska-Mazur K., Gabriel A., Zajecki W., et al. Breast cancer progression and expression of blood group-related tumor-associated antigens. Hybridoma. 2000;19:129-133.
252 Jordon D., Jagirdar J., Kaneko M. Blood group antigens Lewis X and Lewis Y in the diagnostic determination of malignant mesothelioma versus adenocarcinoma. Am J Pathol. 1989;135:931-937.
253 Riera J.R., Astengo-Osuna C., Longmate J.A., et al. The immunohistochemical diagnostic panel for epithelial mesothelioma: a reevaluation after heat-induced epitope retrieval. Am J Surg Pathol. 1997;21:1409-1419.
254 Humphrey P.A. p53: mutations and immunohistochemical detection, with a focus on alterations in urologic malignancies. Adv Pathol Lab Med. 1994;7:579-596.
255 Attanoos R.L., Griffin A., Gibbs A.R. The use of immunohistochemistry in distinguishing reactive from neoplastic mesothelium: a novel use for desmin and comparative evaluation with epithelial membrane antigen, p53, platelet-derived growth factor receptor, P-glycoprotein, and bcl-2. Histopathology. 2003;43:231-238.
256 Esposito V., Baldi A., DeLuca A., et al. p53 immunostaining in differential diagnosis of pleural mesothelial proliferations. Anticancer Res. 1997;17:733-736.
257 Cagle P.T., Brown R.W., Lebovitz R.M. p53 immunostaining in the differentiation of reactive processes from malignancy in pleural biopsy specimens. Hum Pathol. 1994;25:443-448.
258 Kafiri G., Thomas D.M., Shepherd N.A., et al. p53 expression is common in malignant mesothelioma. Histopathology. 1992;21:331-332.
259 Dei Tos A.P., Doglioni C. Calretinin: a novel tool for diagnostic immunohistochemistry. Adv Anat Pathol. 1998;5:61-66.
260 Ordóñez N.G. In search of a positive immunohistochemical marker for mesothelioma: an update. Adv Anat Pathol. 1998;5:53-60.
261 Miettinen M., Sarlomo-Rikala M. Expression of calretinin, thrombomodulin, keratin 5, and mesothelin in lung carcinomas of different types: an immunohistochemical analysis of 596 tumors in comparison with epithelioid mesotheliomas of the pleura. Am J Surg Pathol. 2003;27:150-158.
262 Abutaily A.S., Addis B.J., Roche W.R. Immunohistochemistry in the distinction between malignant mesothelioma and pulmonary adenocarcinoma: a critical evaluation of new antibodies. J Clin Pathol. 2002;55:662-668.
263 Gotzos V., Vogt P., Celio M.R. The calcium binding protein calretinin is a selective marker for malignant pleural mesotheliomas of the epithelial type. Pathol Res Pract. 1996;192:137-147.
264 Doglioni C., Dei Tos A.P., Laurino L., et al. Calretinin: a novel immunocytochemical marker for mesothelioma. Am J Surg Pathol. 1996;20:1037-1046.
265 Attanoos R.L., Dojcinov S.D., Webb R., et al. Anti-mesothelial markers in sarcomatoid mesothelioma and other spindle-cell neoplasms. Histopathology. 2000;37:224-231.
266 Lucas D.R., Pass H.I., Madan S.K., et al. Sarcomatoid mesothelioma and its histological mimics: a comparative immunohistochemical study. Histopathology. 2003;42:270-279.
267 Haber D.A., Buckler A.J., Glaser T., et al. An internal deletion within an 11p13 zinc finger gene contributes to the development of Wilms’ tumor. Cell. 1990;61:1257-1269.
268 Loeb D.M., Sukumar S. The role of WT1 in oncogenesis: tumor suppressor or oncogene? Int J Hematol. 2002;76:117-126.
269 Gulyas M., Hjerpe A. Proteoglycans and WT1 as markers for distinguishing adenocarcinoma, epithelioid mesothelioma, and benign mesothelium. J Pathol. 2003;199:479-487.
270 Foster M.R., Johnson J.E., Olson S.J., et al. Immunohistochemical analysis of nuclear versus cytoplasmic staining of WT1 in malignant mesotheliomas and primary pulmonary adenocarcinomas. Arch Pathol Lab Med. 2001;125:1316-1320.
271 Oates J., Edwards C. HBME-1, MOC-31, WT1, and calretinin: an assessment of recently-described markers for mesothelioma and adenocarcinoma. Histopathology. 2000;36:341-347.
272 Campbell C.E., Kuriyan N.P., Rackley R.R., et al. Constitutive expression of the Wilms tumor suppressor gene (WT1) in renal cell carcinoma. Int J Cancer. 1998;78:182-188.
273 Goldstein N.S., Bassi D., Uzieblo A. WT1 is an integral component of an antibody panel to distinguish pancreaticobiliary and some ovarian epithelial neoplasms. Am J Clin Pathol. 2001;116:246-252.
274 Ueda T., Oji Y., Naka N., et al. Overexpression of the Wilms tumor gene WT1 in human bone and soft tissue sarcomas. Cancer Sci. 2003;94:271-276.
275 Tsuta K., Kato Y., Tochigi N., et al. Comparison of different clones (WT49 versus 6F-H2) of WT-1 antibodies for immunohistochemical diagnosis of malignant pleural mesothelioma. Appl Immunohistochem Mol Morphol. 2009;17:126-130.
276 Esmon C.T. The protein C pathway. Chest. 2003;124(suppl 3):26S-32S.
277 Ishii H., Nakano M., Tsubouchi J., et al. Distribution of thrombomodulin in human tissues and characterization of thrombomodulin in plasma. Acta Hematol Jpn. 1988;51:1228-1233.
278 Boffa M.C., Burke B., Haudenschild C. Different localization of thrombomodulin. Ann Biol Clin. 1987;45:191-197.
279 Attanoos R.L., Goddard H., Gibbs A.R. Mesothelioma-binding antibodies: thrombomodulin, OV632, and HBME-1 and their use in the diagnosis of malignant mesothelioma. Histopathology. 1996;29:209-215.
280 Pu R.T., Pang Y., Michael C.W. Utility of WT-1, p63, MOC31, mesothelin, and cytokeratin (K903 and CK5/6) immunostains in differentiating adenocarcinoma, squamous cell carcinoma, and malignant mesothelioma in effusions. Diagn Cytopathol. 2008;36:20-25.
281 Appleton M.A., Attanoos R.L., Jasani B. Thrombomodulin as a marker of vascular and lymphatic tumors. Histopathology. 1996;29:153-157.
282 Breiteneder-Geleff S., Matsui K., Soleiman A., et al. Podoplanin, novel 43-kd membrane protein of glomerular epithelial cells, is down-regulated in puromycin nephrosis. Am J Pathol. 1997;151:1141-1152.
283 Kalof A.N., Cooper K. D2-40 immunohistochemistry—so far. Adv Anat Pathol. 2009;16:62-64.
284 Hu Y., Yang Q., McMahon L.A., et al. Value of D2-40 in the differential diagnosis of pleural neoplasms with emphasis on its positivity in solitary fibrous tumor. Appl Immunohistochem Mol Morphol. 2010;18:411–413.
285 Shintaku M., Honda T., Sakai T. Expression of podoplanin and calretinin in meningioma: an immunohistochemical study. Brain Tumor Pathol. 2010;27:23-27.
286 Naito Y., Ishii G., Kawai O., et al. D2-40-positive solitary fibrous tumors of the pleura: diagnostic pitfall of biopsy specimen. Pathol Int. 2007;57:618-621.
287 Ordóñez N.G. The diagnostic utility of immunohistochemistry in distinguishing between epithelioid mesotheliomas and squamous carcinomas of the lung: a comparative study. Mod Pathol. 2006;19:417-428.
288 Hanna A., Pang Y., Bedrossian C.W., et al. Podoplanin is a useful marker for identifying mesothelioma in malignant effusions. Diagn Cytopathol. 2010;38:264-269.
289 Marchevsky A.M. Application of immunohistochemistry to the diagnosis of malignant mesothelioma. Arch Pathol Lab Med. 2008;132:397-401.
290 Hinterberger M., Reineke T., Storz M., et al. D2-40 and calretinin—a tissue microarray analysis of 341 malignant mesotheliomas with emphasis on sarcomatoid differentiation. Mod Pathol. 2007;20:248-255.
291 Ordóñez N.G. Immunohistochemical diagnosis of epithelioid mesothelioma: an update. Arch Pathol Lab Med. 2005;129:1407-1414.
292 Ordóñez N.G. D2-40 and podoplanin are highly specific and sensitive immunohistochemical markers of epithelioid malignant mesothelioma. Hum Pathol. 2005;36:372-380.
293 Kenmotsu H., Ishii G., Nagai K., et al. Pleomorphic carcinoma of the lung expressing podoplanin and calretinin. Pathol Int. 2008;58:771-774.
294 Padgett D.M., Cathro H.P., Wick M.R., et al. Podoplanin is a better immunohistochemical marker for sarcomatoid mesothelioma than calretinin. Am J Surg Pathol. 2008;32:123-127.
295 Ordóñez N.G. The immunohistochemical diagnosis of mesothelioma: differentiation of mesothelioma and lung adenocarcinoma. Am J Surg Pathol. 1989;13:276-291.
296 Gibbs A.R., Harach R., Wagner J.C., et al. Comparison of tumor markers in malignant mesothelioma and pulmonary adenocarcinoma. Thorax. 1985;40:91-95.
297 Kawai T., Suzuki M., Torikata C., et al. Expression of blood group-related antigens and Helix pomatia agglutinin in malignant pleural mesothelioma and pulmonary adenocarcinoma. Hum Pathol. 1991;22:118-124.
298 Ordóñez N.G. Value of mesothelin immunostaining in the diagnosis of mesothelioma. Mod Pathol. 2003;16:192-197.
299 Frierson H.F., Moskaluk C.A., Powell S.M., et al. Large-scale molecular and tissue microarray analysis of mesothelin expression in common human carcinomas. Hum Pathol. 2003;34:605-609.
300 Cheung C.C., Ezzat S., Freeman J.L., et al. Immunohistochemical diagnosis of papillary thyroid carcinoma. Mod Pathol. 2001;14:338-342.
301 Fetsch P.A., Abati A., Higazi Y.M. Utility of the antibodies CA19-9, HBME-1, and thrombomodulin in the diagnosis of malignant mesothelioma and adenocarcinoma in cytology. Cancer. 1998;84:101-108.
302 Bateman A.C., Al-Talib R.K., Newman T., et al. Immunohistochemical phenotype of malignant mesothelioma: predictive value of CA125 and HBME-1 expression. Histopathology. 1997;30:49-56.
303 Loy T.S., Quesenberry J.T., Sharp S.C. Distribution of CA-125 in adenocarcinomas: an immunohistochemical study of 481 cases. Am J Clin Pathol. 1992;98:175-179.
304 Mayall F.G., Jasani B., Gibbs A.R. Immunohistochemical positivity for neuron-specific enolase and Leu-7 in malignant mesotheliomas. J Pathol. 1991;165:325-328.
305 Kim M.K., Kim S. Immunohistochemical profile of common epithelial neoplasms arising in the kidney. Appl Immunohistochem Molec Morphol. 2002;10:332-338.
306 Fan Z., van de Rijn M., Montgomery K., et al. Hep-Par1 antibody staining for the differential diagnosis of hepatocellular carcinoma: 676 tumors tested using tissue microarrays and conventional tissue sections. Mod Pathol. 2003;16:137-144.
307 Cohen A.J., Bunn P.A., Franklin W., et al. Neutral endopeptidase: variable expression in human lung, inactivation in lung cancer, and modulation of peptide-induced calcium flux. Cancer Res. 1996;56:831-839.
308 Chu P.G., Arber D.A., Weiss L.M. Expression of T/NK-cell and plasma cell antigens in nonhematopoietic epithelioid neoplasms. Am J Clin Pathol. 2003;120:64-70.
309 Kushitani K., Takeshima Y., Amatya V.J., et al. Immunohistochemical marker panels for distinguishing between epithelioid mesothelioma and lung adenocarcinoma. Pathol Int. 2007;57:190-199.
310 Jaffer S., Orta L., Sunkara S., et al. Immunohistochemical detection of antiapoptotic protein X-linked inhibitor of apoptosis in mammary carcinoma. Hum Pathol. 2007;38:864-870.
311 Wu M., Sun Y., Li G., et al. Immunohistochemical detection of XIAP in mesothelium and mesothelial lesions. Am J Clin Pathol. 2007;128:783-787.
312 Lyons-Boudreaux V., Mody D.R., Zhai J., et al. Cytologic malignancy versus benignancy: how useful are the “newer” markers in body fluid cytology? Arch Pathol Lab Med. 2008;132:23-28.
313 Hanley K.Z., Facik M.S., Bourne P.A., et al. Utility of anti-L523S antibody in the diagnosis of benign and malignant serous effusions. Cancer. 2008;114:49-56.
314 Yuan Y., Nymoen D.A., Stavnes H.T., et al. Tenascin-X is a novel diagnostic marker of malignant mesothelioma. Am J Surg Pathol. 2009;33:1673-1682.
315 Beasley M.B. Immunohistochemistry of pulmonary and pleural neoplasia. Arch Pathol Lab Med. 2008;132:1062-1072.
316 Gordon I.O., Sitterding S., Mackinnon A.C., et al. Update in neoplastic lung diseases and mesothelioma. Arch Pathol Lab Med. 2009;133:1106-1115.
317 Laury A.R., Hornick J.L., Perets R., et al. PAX8 reliably distinguishes ovarian serous tumors from malignant mesothelioma. Am J Surg Pathol. 2010;34:627-635.
318 Husain A.N., Colby T.V., Ordóñez N.G., et al. Guidelines for pathologic diagnosis of malignant mesothelioma: a consensus statement from the International Mesothelioma Interest Group. Arch Pathol Lab Med. 2009;133:1317-1331.
319 Brown R.W., Clark G.M., Tandon A.K., et al. Multiple-marker immunohistochemical phenotypes distinguishing malignant pleural mesothelioma from pulmonary adenocarcinoma. Hum Pathol. 1993;24:347-354.
320 Yaziji H., Battifora H., Barry T.S., et al. Evaluation of 12 antibodies for distinguishing epithelioid mesothelioma from adenocarcinoma: identification of a three-antibody immunohistochemical panel with maximal sensitivity and specificity. Mod Pathol. 2006;19:514-523.
321 Marchevsky A.M., Wick M.R. Evidence-based guidelines for the utilization of immunostains in diagnostic pathology: pulmonary adenocarcinoma versus mesothelioma. Appl Immunohistochem Mol Morphol. 2007;15:140-144.
322 King J., Thatcher N., Pickering C., et al. Sensitivity and specificity of immunohistochemical antibodies used to distinguish between benign and malignant pleural disease: a systematic review of published reports. Histopathology. 2006;49:561-568.
323 Westfall D.E., Fan X., Marchevsky A.M. Evidence-based guidelines to optimize the selection of antibody panels in cytopathology: pleural effusions with malignant epithelioid cells. Diagn Cytopathol. 2010;38:9-14.
324 Bueno R., De Rienzo A., Dong L., et al. Second generation sequencing of the mesothelioma tumor genome. PLoS ONE. 2010;5:e10612.
325 Segers K., Ramael M., Singh S., et al. Detection of numerical chromosomal aberrations in paraffin-embedded malignant pleural mesothelioma by non-isotopic in-situ hybridization. J Pathol. 1995;175:219-226.
326 Shivapurkar N., Virmani A.K., Wistuba I., et al. Deletions of chromosome 4 at multiple sites are frequent in malignant mesothelioma and small-cell lung carcinoma. Clin Cancer Res. 1999;5:17-23.
327 Bjorkqvist A.M., Wolf M., Nordling S., et al. Deletions at 14q in malignant mesothelioma detected by microsatellite marker analysis. Br J Cancer. 1999;81:1111-1115.
328 Lee W.C., Balsara B., Liu Z., et al. Loss of heterozygosity analysis defines a critical region in chromosome 1p22 commonly deleted in human malignant mesothelioma. Cancer Res. 1996;56:4297-4301.
329 Huncharek M. Genetic factors in the etiology of malignant mesothelioma. Eur J Cancer. 1995;31A:1741-1747.
330 Garlepp M.J., Leong C.C. Biological and immunological aspects of malignant mesothelioma. Eur Respir J. 1995;8:643-650.
331 Popescu N.C., Chahinian A.P., DiPaolo J.A. Nonrandom chromosome alterations in human malignant mesothelioma. Cancer Res. 1988;48:142-147.
332 Illei P.B., Rusch V.W., Zakowski M.F., et al. Homozygous deletion of CDKN2A and codeletion of the methylthioadenosine phosphorylase gene in the majority of pleural mesotheliomas. Clin Cancer Res. 2003;9:2108-2113.
333 Dreyling M.H., Bohlander S.K., Adeyanju M.O., et al. Detection of CDKN2 deletions in tumor cell lines and primary glioma by interphase fluorescence in-situ hybridization. Cancer Res. 1995;55:984-988.
334 Cheng J.Q., Jhanwar S.C., Lu Y.Y., et al. Homozygous deletions within 9p21-p22 identify a small critical region of chromosomal loss in human malignant mesotheliomas. Cancer Res. 1993;53:4761-4763.
335 Chiosea S., Krasinskas A., Cagle P.T., et al. Diagnostic importance of 9p21 homozygous deletion in malignant mesotheliomas. Mod Pathol. 2008;21:742-747.
336 Kitamura F., Araki S., Suzuki Y., et al. Assessment of the mutations of the p53 suppressor gene and Ha- and Ki-ras oncogenes in malignant mesothelioma in relation to asbestos exposure: a study of 12 American patients. Ind Health. 2002;40:175-181.
337 Roberts F., McCall A.E., Burnett R.A. Malignant mesothelioma: a comparison of biopsy and postmortem material by light microscopy and immunohistochemistry. J Clin Pathol. 2001;54:766-770.
338 Mayall F.G., Jacobson G., Wilkins R. Mutations of the p53 gene and SV40 sequences in asbestos-associated and non-asbestos-associated mesotheliomas. J Clin Pathol. 1999;52:291-293.
339 Murthy S.S., Testa J.R. Asbestos, chromosomal deletions, and tumor suppressor gene alterations in human malignant mesothelioma. J Cell Physiol. 1999;180:150-157.
340 Liu B.C., Fu D.C., Miao Q., et al. p53 gene mutations in asbestos-associated cancers. Biomed Environ Sci. 1998;11:226-232.
341 Kirao T., Bueno R., Chen C.J., et al. Alterations of the p16 (INK4) locus in human malignant mesothelial tumors. Carcinogenesis. 2002;23:1127-1130.
342 Van der Meerden A., Seddon M.B., Betscholtz C.A., et al. Tumorigenic conversion of human mesothelial cells as a consequence of platelet-derived growth factor-A chain overexpression. Am J Respir Cell Molec Biol. 1993;8:214-221.
343 Tolnay E., Kuhnen C., Wiethage T., et al. Hepatocyte growth factor/scatter factor and its receptor c-met are overexpressed and associated with an increased microvessel density in malignant pleural mesothelioma. J Cancer Res Clin Oncol. 1998;124:291-296.
344 Hodzic D., Delacroix L., Willemsen P., et al. Characterization of the IGF system and analysis of the possible molecular mechanisms leading to IGF-II overexpression in mesothelioma. Horm Metab Res. 1997;29:549-555.
345 Kumar-Singh S., Weyler J., Martin M.J., et al. Angiogenic cytokines in mesothelioma: a study of VEGF, FGF-1 and 2, and TGF-beta expression. J Pathol. 1999;189:72-78.
346 Segers K., Ramael M., Singh S.K., et al. Immunoreactivity for bcl-2 protein in malignant mesothelioma and non-neoplastic mesothelium. Virchows Arch A. 1994;424:631-634.
347 Sekido Y. Molecular biology of malignant mesothelioma. Environ Health Prev Med. 2008;13:65-70.
348 Horvai A.E., Li L., Xu Z., et al. Malignant mesothelioma does not demonstrate overexpression or gene amplification despite cytoplasmic immunohistochemical staining for c-erbB-2. Arch Pathol Lab Med. 2003;127:465-469.
349 Ramos-Nino M.E., Timblin C.R., Mossman B.T. Mesothelial cell transformation requires AP-1 binding activity and ERK-dependent Fra-1 expression. Cancer Res. 2002;62:6065-6069.
350 Saad R.S., Cho P., Liu Y.L., et al. The value of epithelial membrane antigen expression in separating benign mesothelial proliferation from malignant mesothelioma: a comparative study. Diagn Cytopathol. 2005;32:156-159.
351 Shen J., Pinkus G.S., Deshpande V., et al. Usefulness of EMA, GLUT-1, and XIAP for the cytologic diagnosis of malignant mesothelioma in body cavity fluids. Am J Clin Pathol. 2009;131:516-523.
352 Hasteh F., Lin G.Y., Weidner N., et al. The use of immunohistochemistry to distinguish reactive mesothelial cells from malignant mesothelioma in cytologic effusions. Cancer Cytopathol. 2010;118:90-96.
353 Illei P.B., Ladanyi M., Rusch V.W., et al. The use of CDKN2A deletion as a diagnostic marker for malignant mesothelioma in body cavity effusions. Cancer. 2003;99:51-56.
354 Mangano W.E., Cagle P.T., Churg A., et al. The diagnosis of desmoplastic malignant mesothelioma and its distinction from fibrous pleurisy: a histologic and immunohistochemical analysis of 31 cases including p53 immunostaining. Am J Clin Pathol. 1998;110:191-199.
355 Nakatsuka S., Yao M., Hoshida Y., et al. Pyothorax-associated lymphoma: a review of 106 cases. J Clin Oncol. 2002;20:4255-4260.
356 Wakely P.E.Jr, Menezes G., Nuovo G. Primary effusion lymphoma: cytopathologic diagnosis using in-situ molecular genetic analysis for human herpesvirus 8. Mod Pathol. 2002;15:944-950.
357 Aquino S.L., Chen M.Y., Kuo W.T., et al. The CT appearance of pleural and extrapleural disease in lymphoma. Clin Radiol. 1999;54:647-650.
358 Lee M.J., Grogan L., Meehan S., et al. Pleural granulocytic sarcoma: CT characteristics. Clin Radiol. 1991;43:57-59.
359 Colonna A., Gualco G., Bacchi C.E., et al. Plasma cell myeloma presenting with diffuse pleural involvement: a hitherto unreported pattern of a new mesothelioma mimicker. Ann Diagn Pathol. 2010;14:30-35.
360 Blakolmer K., Essop M.F., Close P.M. Diagnosis of an anemone cell tumor as a B-cell lymphoma by molecular analysis. Ultrastruct Pathol. 1996;20:189-193.
361 Nappi O., Boscaino A., Wick M.R. Extramedullary hematopoietic proliferations, extraosseous plasmacytomas, and ectopic splenic implants (splenosis). Semin Diagn Pathol. 2003;20:338-356.
362 Inoue K., Ogawa H., Sonoda Y., et al. Aberrant overexpression of the Wilms tumor gene (WT1) in human leukemia. Blood. 1997;89:1405-1412.
363 Hirose M., Kuroda Y. p53 may mediate mdr-1 expression via the WT1 gene in human vincristine-resistant leukemia/lymphoma cell lines. Cancer Lett. 1998;129:165-171.
364 Lin B.T., Colby T.V., Gown A.M., et al. Malignant vascular tumors of the serous membranes mimicking mesothelioma. A report of 14 cases. Am J Surg Pathol. 1996;20:1431-1439.
365 Zhang P.J., LiVolsi V.A., Brooks J.J. Malignant epithelioid vascular tumors of the pleura: report of a series and literature review. Hum Pathol. 2000;31:29-34.
366 Ximenes M.III, Miziara H.L. Hemangioendothelioma of the lung and pleura: report of three cases. Int Surg. 1981;55:67-70.
367 Battifora H. Epithelioid hemangioendothelioma imitating mesothelioma. Appl Immunohistochem. 1993;1:220-222.
368 Del Frate C., Mortele K., Zanardi R., et al. Pseudomesotheliomatous angiosarcoma of the chest wall and pleura. J Thorac Imaging. 2003;18:200-203.
369 McKay B., Ordóñez N.G., Huang W.L. Ultrastructural and immunocytochemical observations on angiosarcomas. Ultrastruct Pathol. 1989;13:97-110.
370 Weiss S.W., Enzinger F.M. Epithelioid hemangioendothelioma: a vascular tumor often mistaken for a carcinoma. Cancer. 1982;50:970-981.
371 Miettinen M., Fetsch J.F. Distribution of keratins in normal endothelial cells and a spectrum of vascular tumors: implications in tumor diagnosis. Hum Pathol. 2000;31:1062-1067.
372 Miettinen M., Lindenmayer A.E., Chaubal A. Endothelial cell markers CD31, CD34, and BNH9 antibody to H- and Y- antigens: evaluation of their specificity and sensitivity in the diagnosis of vascular tumors and comparison with von Willebrand factor. Mod Pathol. 1994;7:82-90.
373 Bahrami A., Allen T.C., Cagle P.T. Pulmonary epithelioid hemangioendothelioma mimicking mesothelioma. Pathol Int. 2008;58:730-734.
374 Panagopoulos I., Mertens F., Isaksson M., et al. Molecular genetic characterization of the EWS/CHN and RBP56/CHN fusion genes in extraskeletal myxoid chondrosarcoma. Genes Chromosomes Cancer. 2002;35:340-352.
375 Goetz S.P., Robinson R.A., Landas S.K. Extraskeletal myxoid chondrosarcoma of the pleura: report of a case clinically simulating mesothelioma. Am J Clin Pathol. 1992;97:498-502.
376 Okamoto S., Hisaoka M., Ishida T., et al. Extraskeletal myxoid chondrosarcoma: a clinicopathologic, immunohistochemical, and molecular analysis of 18 cases. Hum Pathol. 2001;32:1116-1124.
377 Dei Tos A.P., Wadden C., Fletcher C.D.M. Extraskeletal myxoid chondrosarcoma: an immunohistochemical reappraisal of 39 cases. Appl Immunohistochem. 1997;5:73-77.
378 Daugaard S., Christensen L.H., Høgdall E. Markers aiding the diagnosis of chondroid tumors: an immunohistochemical study including osteonectin, bcl-2, cox-2, actin, calponin, D2-40 (podoplanin), mdm-2, CD117 (c-kit), and YKL-40. APMIS. 2009;117:518-525.
379 Litzky L.A. Pulmonary sarcomatous tumors. Arch Pathol Lab Med. 2008;132:1104-1117.
380 Fisher C. Synovial sarcoma. Ann Diagn Pathol. 1998;2:401-421.
381 Miettinen M., Limon J., Niezabitowski A., et al. Calretinin and other mesothelial markers in synovial sarcoma: analysis of antigenic similarities and differences with malignant mesothelioma. Am J Surg Pathol. 2001;25:610-617.
382 Knösel T., Heretsch S., Altendorf-Hofmann A., et al. TLE1 is a robust diagnostic biomarker for synovial sarcomas and correlates with t(X;18): analysis of 319 cases. Eur J Cancer. 2010;46:1170-1176.
383 Carbone M., Rizzo P., Powers A., et al. Molecular analyses, morphology, and immunohistochemistry together differentiate pleural synovial sarcoma from mesotheliomas: clinical implications. Anticancer Res. 2002;22:3443-3448.
384 Nappi O., Glasner S.D., Swanson P.E., et al. Biphasic and monophasic sarcomatoid carcinomas of the lung. Am J Clin Pathol. 1994;102:331-340.
385 Falconieri G., Zanconati F., Bussani R., et al. Small cell carcinoma of the lung simulating pleural mesothelioma: report of 4 cases with autopsy confirmation. Pathol Res Pract. 1995;191:1147-1152.
386 Wick M.R. Immunohistology of neuroendocrine and neuroectodermal tumors. Semin Diagn Pathol. 2000;17:194-203.
387 Beiske K., Myklebust A.T., Aamdal S., et al. Detection of bone marrow metastases in small cell lung carcinoma patients: comparison of immunologic and morphologic methods. Am J Pathol. 1992;141:531-538.
388 Chhieng D.C., Ko E.C., Yee H.T., et al. Malignant pleural effusions due to small cell lung carcinoma: a cytologic and immunocytochemical study. Diagn Cytopathol. 2001;25:356-360.
389 Attanoos R.L., Galateau-Sallé F., Gibbs A.R., et al. Primary thymic epithelial tumors of the pleura mimicking malignant mesothelioma. Histopathology. 2002;41:42-49.
390 DiComo C.J., Urist M.J., Babayan I., et al. p63 expression profiles in human normal and tumor tissues. Clin Cancer Res. 2002;8:494-501.
391 Hammond E.H., Flinner R.L. The diagnosis of thymoma: a review. Ultrastruct Pathol. 1991;15:419-438.
392 Flint A., Weiss S.W. CD34 and keratin expression distinguishes solitary fibrous tumor (fibrous mesothelioma) of pleura from desmoplastic mesothelioma. Hum Pathol. 1995;26:428-431.
393 Gaffey M.J., Mills S.E., Ritter J.H. Clear cell tumors of the lower respiratory tract. Semin Diagn Pathol. 1997;14:222-232.
394 Fleming S. Genetics of renal tumours. Cancer Metastasis Rev. 1997;16:127-140.
395 Osborn M., Pelling N., Walker M.M., et al. The value of “mesothelium-associated” antibodies in distinguishing between metastatic renal cell carcinomas and mesotheliomas. Histopathology. 2002;41:301-307.
396 Tong G.X., Chiriboga L., Hamele-Bena D., et al. Expression of PAX2 in papillary serous carcinoma of the ovary: immunohistochemical evidence of fallopian tube or secondary Müllerian system origin? Mod Pathol. 2007;20:856-863.
397 Herrera G.A., Turbat-Herrera E.A. The role of ultrastructural pathology in the diagnosis of epithelial and unusual renal tumors. Ultrastruct Pathol. 1996;20:7-26.
398 Nappi O., Ferrara G., Wick M.R. Neoplasms composed of eosinophilic polygonal cells: an overview with consideration of different cytomorphologic patterns. Semin Diagn Pathol. 1999;16:82-90.
399 Mackay B., El-Naggar A., Ordóñez N.G. Ultrastructure of adrenal cortical carcinoma. Ultrastruct Pathol. 1994;18:181-190.
400 DeYoung B.R., Wick M.R. Immunohistologic analysis of metastatic carcinomas of unknown origin: an algorithmic approach. Semin Diagn Pathol. 2000;17:184-193.
401 Gaffey M.J., Traweek S.T., Mills S.E., et al. Cytokeratin expression in adrenocortical neoplasia. Hum Pathol. 1992;23:144-153.
402 Zhang P.J., Genega E.M., Tomaszewski J.E., et al. The role of calretinin, inhibin, melan-A, bcl-2, and c-kit in differentiating adrenal cortical and medullary tumors: an immunohistochemical study. Mod Pathol. 2003;16:591-597.
403 Vaideeswar P., Deshpande J.R., Jambhekar N.A. Primary pleuropulmonary malignant germ cell tumors. J Postgrad Med. 2002;48:29-31.
404 Srigley J.R., Mackay B., Toth P., et al. The ultrastructure and histogenesis of male germ cell neoplasia with emphasis on seminoma with early carcinomatous features. Ultrastruct Pathol. 1988;12:67-86.
405 Devouassoux-Shisheboran M., Manduit C., Tabone E., et al. Growth regulating factors and signalling proteins in testicular germ cell tumors. APMIS. 2003;111:212-224.
406 Biermann K., Klingmüller D., Koch A., et al. Diagnostic value of markers M2A, OCT3/4, AP-2gamma, PLAP and c-KIT in the detection of extragonadal seminomas. Histopathology. 2006;49:290-297.
407 Horvai A.E., Li L., Xu Z., et al. c-kit is not expressed in malignant mesothelioma. Mod Pathol. 2003;16:818-822.
408 Brooks J.J., LiVolsi V.A., Pietra G.G. Mesothelial cell inclusions in mediastinal lymph nodes, mimicking metastatic carcinoma. Am J Clin Pathol. 1990;93:741-748.
409 Parkash V., Vidwans M., Carter D. Benign mesothelial cells in mediastinal lymph nodes. Am J Surg Pathol. 1999;23:1264-1269.
410 Isotalo P.A., Veinot J.P., Jabi M. Hyperplastic mesothelial cells in mediastinal lymph node sinuses with extranodal lymphatic involvement. Arch Pathol Lab Med. 2000;124:609-613.
411 Hoekman K., Tognon G., Risse E.K., et al. Well-differentiated papillary mesothelioma of the peritoneum: a separate entity. Eur J Cancer. 1996;32A:255-258.
412 Weiss S.W., Tavassoli F.A. Multicystic mesothelioma: an analysis of pathologic findings and biologic behavior in 37 cases. Am J Surg Pathol. 1988;12:737-746.
413 Butnor K.J., Sporn T.A., Hammar S.P., et al. Well-differentiated papillary mesothelioma. Am J Surg Pathol. 2001;25:1304-1309.
414 Galateau-Sallé F., Vignaud J.M., Burke L., et al. Well-differentiated papillary mesothelioma of the pleura: a series of 24 cases. Am J Surg Pathol. 2004;28:534-540.
415 Yesner R., Hurwitz A. Localized pleural mesothelioma of epithelial type. J Thorac Surg. 1953;26:325-329.
416 Ball N.J., Urbanski S.J., Green F.H., et al. Pleural multicystic mesothelial proliferation: the so-called “multicystic mesothelioma.”. Am J Surg Pathol. 1990;14:375-378.
417 Kao S., Mahon K., Lin B., et al. Pleural well-differentiated papillary mesothelioma: a case report. J Thorac Oncol. 2009;4:920-922.
418 Torii I., Hashimoto M., Terada T., et al. Well-differentiated papillary mesothelioma with invasion to the chest wall. Lung Cancer. 2010;67:244-247.
419 Butchart E.G., Ashcroft T., Barnsley W.C., et al. Pleuropneumonectomy in the management of diffuse malignant mesothelioma of the pleura: experience with 29 patients. Thorax. 1976;31:15-24.
420 Rusch V.W. A proposed new international TNM staging system for malignant pleural mesothelioma from the International Mesothelioma Interest Group. Lung Cancer. 1996;14:1-12.
421 Greene F.L., editor. American Joint Committee on Cancer (AJCC) Cancer Staging Manual, 6th ed. Springer-Verlag, New York, 2002;139-141.
422 Sugarbaker D.J., Strauss G.M., Lynch T.J., et al. Node status has prognostic significance in the multimodality therapy of diffuse malignant mesothelioma. J Clin Oncol. 1993;11:1172-1178.
423 Koong H.N., Battafarano R.J., Ginsberg R.J. Malignant pleural mesothelioma, 2nd ed. Gospodarowicz M.K., Henson D.E., Hutter R.V.P., et al, editors. Prognostic Factors in Cancer. Wiley-Liss, New York, 2001;371-385.
424 Johansson L., Linden C.J. Aspects of histopathologic subtype as a prognostic factor in 85 pleural mesotheliomas. Chest. 1996;109:109-114.
425 Rusch V.W., Venkatraman E.S. Important prognostic factors in patients with malignant pleural mesothelioma, managed surgically. Ann Thorac Surg. 1999;68:1799-1804.
426 Metintas M., Metintas S., Ucgun I., et al. Prognostic factors in diffuse malignant pleural mesothelioma: effects of pretreatment clinical and laboratory characteristics. Respir Med. 2001;95:829-835.
427 Beer T.W., Shepherd P., Pullinger N.C. p27 immunostaining is related to prognosis in malignant mesothelioma. Histopathology. 2001;38:535-541.
428 Bongiovanni M., Cassoni P., DeGiuli P., et al. p27 (kip1) immunoreactivity correlates with long-term survival in pleural malignant mesothelioma. Cancer. 2001;92:1245-1250.
429 Leonardo E., Zanconati F., Bonifacio D., Bonito L.D. Immunohistochemistry for MIB-1 and p27/kip1 as a prognostic factor for pleural mesothelioma. Pathol Res Pract. 2001;197:253-256.
430 Dacic S., Kothmaier H., Land S., et al. Prognostic significance of p16/cdkn2a loss in pleural malignant mesotheliomas. Virchows Arch. 2008;453:627-635.
431 Comin C.E., Anichini C., Boddi V., et al. MIB-1 proliferation index correlates with survival in pleural malignant mesothelioma. Histopathology. 2000;36:26-31.
432 Alifano M., Loi M., Camilleri-Broet S., et al. Neurotensin expression and outcome of malignant pleural mesothelioma. Biochimie. 2010;92:164-170.
433 Cappia S., Righi L., Mirabelli D., et al. Prognostic role of osteopontin expression in malignant pleural mesothelioma. Am J Clin Pathol. 2008;130:58-64.
434 Baldi A., Mottolese M., Vincenzi B., et al. The serine protease HtrA1 is a novel prognostic factor for human mesothelioma. Pharmacogenomics. 2008;9:1069-1077.
435 Opitz I., Soltermann A., Abaecherli M., et al. PTEN expression is a strong predictor of survival in mesothelioma patients. Eur J Cardiothorac Surg. 2008;33:502-506.
436 Kothmaier H., Quehenberger F., Halbwedl I., et al. EGFR and PDGFR differentially promote growth in malignant epithelioid mesothelioma of short and long term survivors. Thorax. 2008;63:345-351.